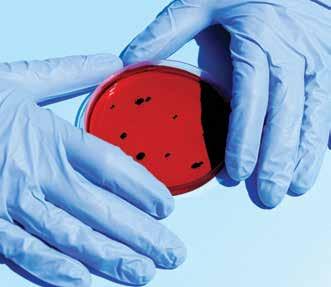

Of The Area NewsCOFFS COAST






By Andrea FERRARI
CURRYFEST 2025, boosted by fabulous weather, saw thousands descend on Woolgoolga between 26 and 28 September.
Visitors discovered and sampled an array of multicultural cuisines, and enjoyed the family entertainment and other cultural delights.
“Turbans were tied, dance moves perfected, taste buds tantalised, curry cooking tips picked up and spice cupboards replenished,” Curryfest Committee Chair Pam Fayle said.
The colours and crowds “were a sight for sore eyes
Page 2












Andrea FERRARI 0410 067 966 andrea@newsofthearea.com.au
Andrew VIVIAN 0414 646 198 andrew@newsofthearea.com.au

Aiden BURGESS aiden@newsofthearea.com.au





David WIGLEY wigley@newsofthearea.com.au
Mike HELY 0427 108 089 mike@newsofthearea.com.au
Kim SATCHELL 0422 016 285 satchell@newsofthearea.com.au
Leigh WATSON 0433 831 403 leigh@newsofthearea.com.au
Doug CONNOR 0431 487 679 doug@newsofthearea.com.au
EDITOR
NEWS DESK: media@newsofthearea.com.au
ADVERTISING: ads@newsofthearea.com.au
FLIPBOOK ONLINE: www.newsofthearea.com.au
: facebook.com/coffsNOTA
FROM Page 1
after last year’s bad weather cancellation”.
Friday night saw hundreds gathered at the reserve to enjoy the movie on the beach, while the early start on Sunday did not stop yoga and meditation enthusiasts from enjoying the Wellness by the Waves event.

Many local cafes joined in with a range of curries on offer over the weekend.
Curryfest organisers say planning is already underway for the big 20th birthday of Curryfest next year.
“We’ll be responding to suggestions for improvements, getting as many more curries as we can and offering a huge entertainment
program as well as aiming for additional add on events to extend the festival,” said Chamber of Commerce and Another Tasty Event representatives.
“We are planning on some exciting improvements.”
To help with planning, organisers would like anyone who attended this year’s Curryfest to complete the survey on the event’s website - curryfest.com.au.

By Andrew VIVIAN
THE National Parks Association of NSW (NPA) hosted 100 community and environmental leaders from across the North Coast to celebrate the announcement of the Great Koala National Park (GKNP).
Among those gathered in Bongil Bongil National Park south of Coffs Harbour last Saturday, 27 September, were NPA CEO Gary Dunnett, Greens MLC Sue Higginson, councillors from three LGAs and representatives and members of the North East Forest Alliance, Nambucca Valley Conservation Association and Bellingen Environment Centre.
The 476,000 hectare park, which includes 176,000 hectares of former state forests - now protected - will increase the National Parks estate on the Mid North Coast by 25 percent and provide sanctuary for up to 20 percent of NSW’s remaining wild koalas.
Ms Higginson said, “We celebrated this incredible victory, the culmination of so much work, by so many people, over such a long time.
“The feeling of joy and relief was palpable.
“Like all of these wins, the work is not over and in many ways it’s just begun.”
She said the GKNP requires lots of work and ongoing management to make it the healthy functional forest ecosystem network that it once was.
Mr Dunnett agreed, “The Great Koala



National Park represents a transformative moment for conservation in NSW.
“This deeply collaborative effort brought together community groups, scientists, businesses, and countless individuals who refused to give up on protecting the best koala habitat in the world.
“This park will be a legacy for generations to come.”
NPA Coffs Coast President Grahame Douglas, said, “We want to thank the Minister for Environment for her support of the GKNP, and indeed thanks to the NSW Government for considering the science and understanding the importance of this decision in such a holistic way.

“The tourism potential this park represents is demonstrated in spades by the scale of this commitment.
“We acknowledge this has been a tough process for all involved, including logging families whose livelihoods have been deeply connected to this industry.”
Nambucca Valley Councillor Ljubov Simson said, “Celebrating today alongside members of our community dedicated to the preservation of our forests, habitat and biodiversity reinforces the importance of working together as custodians and stewards of the land and its people for our sustainable future.”




following streets in Woolgoolga between 5am and 9pm:
• Ocean Street between Carrington Street and Queen Street.
Telephone enquiries should be directed to City of Coffs Harbour on 6648 4000.

FROM Page 1
the discovery of two bodies just after 5pm on Friday.
Local crime manager Detective Inspector Peter O'Reilly said the 61-year-old woman, named as former nurse Carolyn Campbell, had been identified as having lived at the Boambee residence along with her husband.
believed to have been aged in his 60s and was visiting the couple, Insp O'Reilly said.
The dead man, who was still to be formally identified on Saturday afternoon, was
Strike Force Yarnko has been formed to investigate the circumstances surrounding the deaths.
"Local detectives are being assisted by
State Crime Command's Homicide Squad and we are appealing to anyone with information they believe relevant to this investigation to contact Coffs Harbour Police," Det Insp O'Reilly said.
"Initial information provided to investigators
indicates the deceased man was a family friend who had been staying with the couple only a matter of days.
"While the investigation is very much in its early stages, we have no evidence there is anyone else involved in these
By Andrea FERRARI
FIRST
It is a historic milestone.
Founded by artist and designer Melissa Greenwood, a proud Gumbaynggirr, Bundjalung, and Dunghutti
woman, together with her mother and master weaver
Lauren Jarrett, Miimi & Jiinda brings ancestral stories, matriarchal wisdom, and a vision of sustainable luxury to the global fashion stage for the first time.
"This special moment in time belongs to my great grandmothers, grandmothers, mother and





aunties, and my daughterour matriarchal line,” Melissa told News Of The Area.
“What we’ve created is memory woven into garments, now walking proudly on one of the world’s most celebrated stages."
Having taken a step into Europe by establishing their production facility within historic ateliers in Portugal, Melissa feels deeply aligned with the partnership.
“The ateliers we partner with are led by women, carrying the same matriarchal strength and spirit that has always guided Miimi & Jiinda.”
At Paris Fashion Week, Miimi & Jiinda will preview its Spring/Summer 2026 collection, “Gaagal Wanggaan”.
The collection is presented in a dedicated showroom offering the international press, buyers, and industry insiders an




exclusive preview.
Meaning ‘South Beach’ in Gumbaynggirr, Gaagal Wanggaan reflects resilience, belonging, and connection to Country and Earth.
Its palette of soft coastal blues, deep ocean greens, and sandy neutrals evokes the ever-changing interplay of ocean, sand, and sky.
Fluid, timeless silhouettes mirror the rhythm of waves and the Bindarray River, while natural, sustainably sourced fabrics ground the collection in cultural and ecological integrity.
Each piece is designed as a wearable ceremony, carrying the spirit, memory, and stories of Country wherever it is worn.
Miimi & Jiinda works exclusively with high-quality, natural, and responsibly sourced fabrics including European Flax-certified linen, organic cotton, silks, and low-impact denim.




deaths; however, we will be keeping an open mind as we progress our inquiries."
Police do not believe there is any threat to the local community in relation to the incident.
A report will be prepared for the information of the coroner.

Smaller runs and woven adornments continue to be created in Australia, preserving a living connection to homelands.
Each garment is designed on Gumbaynggirr Country to be timeless, collectible, and ceremonial, affirming that true luxury embodies cultural regeneration,














By Ned COWIE
THE Nambucca Valley’s last remaining timber mill is struggling to stay afloat as a result of the Great Koala National Park (GKNP) logging moratorium.
Enforced on 8 September, the temporary ban affects State Forest land previously available for logging.
In a move that has further angered local timber workers, Nambucca Valley Council has rescinded its public opposition to the GKNP.
Owner of Bowraville Sawmill, Matthew Dyer, was joined by more than 60 supporters to hear Council vote on the rescission motion put forward by Labor Party Councillor Susan Jenvey.
The motion was passed, prompting disgruntled members of the public gallery to call out.
Mayor Gary Lee called a point of order and temporarily suspended the meeting.
The group vacated the chamber, but loud discussions in the foyer led to them being asked to vacate the building.
“How would they feel if the situation was reversed and, as their representative, I didn’t vote in support of their business,” Mr Dyer told News Of The Area in response to Council’s backflip.
“I have a viable business

and [through wages, donations and contractors] I believe I contribute around $3.7million (per annum) to the local district.”
He expressed his frustration with proposed redundancies, retraining and relocation packages and his anxiety for the future of his staff, some who have worked with him for decades.
Few doubt that in a town of barely 1000 people like Bowraville, the loss of the timber mill and its associated finances, would take its toll.
Conservationists, however, have applauded the current logging moratorium and say they look forward to renewed tourism opportunities when
the park is established.
In her right of reply before the vote, Cr Jenvey offered her analysis of why the State Government had implemented a moratorium.
“I think that the forest industry or the timber industry might have complicated matters for its own workers,” she said.
“There has been an acceleration of logging within the footprint of the National Park and that’s probably why we are at the stage of a moratorium.
“Last year there was logging in there, at four times the rate of everywhere else.
“We need to look after everyone and move with
the change and take what opportunities we can and if Council can support the timber industry but also support the GKNP that’s a good thing.”
Councillors Smith, Jones, Simson and Ballangarry voted for the motion, acknowledging that while this moratorium on logging was a state government decision and therefore beyond the scope of the Council, it needed to be supported in order to look towards new ventures and ask for appropriate arrangements for misplaced industry workers.
They resolved to:
1) Rescind the resolution of Council to not support the Great Koala National Park.
2) Request the NSW Government provide details of job losses in the timber industry due to the timber harvesting moratorium.
3) Request the NSW Government advise details of the compensation packages available to support businesses and employees affected by the timber harvesting moratorium.
The previous night’s public forum, on Tuesday 16 September, heard a submission from NSW Farmers President Greg Desmond, who urged councillors to vote to keep the 2018 motion in place.
“The new park declaration includes long-standing perpetual grazing leases managed by farmers for over a century, which will negatively impact farm businesses and private native forest operations,” he said.
“They limit farming families and aspiring farmers from buying land to meet the nation’s food and clothing needs.
“This issue will only worsen with the proposed farm purchases in northern NSW to establish plantations for future timber needs, as recently announced.”
Mr Desmond also expressed his concern that National Parks present as “overgrown tinderboxes” and major breeding grounds for
pests and weeds.
Like Matt Dyer and the Bowraville Sawmill, the Adam’s Sawmill at Bonville is facing a grim future.
Federal Nationals Senator for NSW and Shadow Minister for Fisheries and Forestry Ross Cadell, recently toured the business and heard that workers “have been left with little idea on what their future holds”.
“Locals, industry, and politicians alike are in agreement over the need to protect the Koala, but it must not be an all-or-nothing approach,” Senator Cadell said.
“The Minns Labor Government has made this out to be a win for the koala [but] under the canopy, this decision has cost hundreds of jobs and will decimate regional communities.
“With appropriate consultation and consideration of alternate proposals on the size of the proposed park boundary, a win-win scenario can still be achieved.”
Senator Cadell also toured a logging site at Orara East State Forest and the Herons Creek Timber Mills, south of Port Macquarie.
“For decades, these businesses have provided the trusses and frames that have built our nation.
“Right now, they need our support, not to be left out to rot by capital city-centric decision makers.”


A NEW purpose-built lifeguard tower has been installed at Sawtell Main Beach.
Prefabricated by Emineo Engineering Services, the new structure was bolted together on site and took just four days to build.
“For safety reasons, the old tower had to be brought down.”
Featuring three panoramic windows and
“The incredible erosion we saw right across the East Coast undermined a lot of beach infrastructure and that included the old lifeguard tower at Sawtell,” City of Coffs Harbour Mayor Nikki Williams said.
PUBLIC consultation on the City of Coffs Harbour’s Draft Active Transport Plan closes on Tuesday 11 November.
According to Council, the City’s Draft Plan has three key focus areas:
• Make it easier, safer and fun for kids to walk and ride to school with new active transport links and associated infrastructure (eg safer crossings)
• Deliver connected and continuous strategic paths to link our centres, precincts and places; and
• Address missing active transport links for
key walking corridors and bike paths located along busy roads with high speeds.
“We are looking to develop school safe access plans in collaboration with schools and other stakeholders to inform the City’s prioritisation of active transport links to schools,” said Planning and Communities Acting Director Ian Fitzgibbon.
Identifying strategic paths – such as the West Coffs Shared Path Network – is another core focus area.
“This is a long-term ambition as the sheer size
staircase access, the new tower is made of aluminium and has a minimum expiry life of 15 years.
Due to its construction, it can be moved if required.
“It’s being positioned just south of the Surf Club and has great vision up and down the beach,” said City Infrastructure Acting
is patrolled daily from the start of the school holidays in September to the end of the school holidays in April.
City lifeguards patrol the beach on weekdays and the local Surf Life Saving Club is on duty on weekends and public holidays.
Meanwhile, temporary aluminium access steps have been installed at Diggers Beach which was also impacted by erosion.
“The new steps will provide ready access to Diggers and we’re pleased to have them in place in time for the start of the holidays,” Mr Noble said.
DAYLIGHT saving for 2025 starts at 2am AEST on Sunday, 5 October.
Clocks are moved forward by one hour to 3am, giving you more daylight in the evening. Changing your clocks can affect your sleep and daily routine.
The NSW Government offers the following tips to adjust easily: Gradual bedtime changes: adjust your bedtime by 15 minutes each night before the change to help your body transition smoothly.
• Adjust your clocks before bed: to kickstart your day and avoid any timing issues, set your watch and household clocks that don't automatically update overnight to the new time before you go to bed.
• Maximise morning light: get outside in the morning to help reset your body clock.
• Stay consistent: keep your sleep schedule consistent to avoid disruption.
of the projects will make them largely dependent on external funding,” Mr Fitzgibbon said.
“The strategic paths program - when desirable – can tap into our green network of creek corridors, parks and reserves to provide connections between centres and places such as shopping and sports facilities.”
According to Council, the Highway Bypass Project at the northern end of Korora provides an opportunity to complete missing links in the Solitary Islands Way shared path corridor between Coffs
Harbour and the Northern Beaches.
A new shared path from Sapphire Beach south to Korora and through to Charlesworth Bay Road near Pacific Bay Resort will be established as part of the Bypass works.
“That gives us an impetus to investigate funding opportunities for complementary works, such as extending the path network from Charlesworth Bay Road to Coffs Harbour,” Mr Fitzgibbon said.
The Draft Plan’s ‘Missing Links program’ notes the following
opportunities:
• Arthur Street, Park Beach
• Linden Avenue, Toormina/Boambee East
• Shephards Lane, West Coffs Harbour
• Lyons Road, Sawtell
• Crossings on Toormina Road, Toormina
• Crossings on Albany Street, Coffs Harbour; and
• Safer crossings for the Hogbin Drive bike path at the northern end near Harbour Drive and the southern end at Sawtell Road.
The Draft Plan targets
an investment between $600,000 to $1.5 million per annum, which equates to $6 million to $15m over the next 10 years on active transport infrastructure.
The City’s proposed investment in active transport infrastructure will come from a number of sources including the City’s capital works budget, developer contributions, targeted NSW Government grant funding and complementary infrastructure to capital works projects such as road reconstructions and sports field upgrades.
Have your say at https://haveyoursay. coffsharbour.nsw.gov.au/ active-transport-plan.



Call today for advert sizes and prices (02) 4981 8882 ads@newsofthearea.com.au
Email us the exact wording and we will email back a proof and price ads@newsofthearea.com.au
Phone us : Mon, Tue or Wed mornings Phone line Open 10am -12noon (02) 4981 8882
Where to Find your Newspaper
Available in newsstands & counters of over 100 businesses & locations throughout Coffs Coast. Some include, supermarkets, newsagents, convenience stores, shopping centres, chemists, service stations, real estate agents, many general businesses throughout the area.
A list is published towards the back of this newspaper. You can also find the outlets by going to www.newsofthearea.com.au
15,000 copies

By Andrea FERRARI
BISHOP Druitt College (BDC) former student and now teacher at the college, Kayla Baker, has achieved Gold in the Duke of Edinburgh’s Award - the program’s highest level of achievement.
The Duke of Edinburgh’s Award is a non-competitive, globally recognised youth development program that fosters personal growth, resilience, leadership, and community engagement.
Open to all young Australians aged 14-24, it requires participants to complete activities across four key sections: Volunteering, Physical Recreation, Skills, and Adventurous Journey.
A Residential Project is also required at the Gold level.
Kayla’s journey included volunteering for Outside School Hours Care programs; skills development through learning scrapbooking, cooking, and photography; physical recreation through playing Oztag and taking on adventurous journeys from canoeing along the Bellinger River to completing sections of the Yuraygir Track, Washpool National Park, and the Great North Walk.
To qualify for the Gold Award, the fifth component of participating in a residential project, Kayla went on a cultural immersion to Cambodia with BDC.
“I saw the information about it in the


college newsletter and thought this is a challenge for me,” Kayla said.
“It wasn’t easy as I faced COVID, university commitments, and the personal loss of my father, but I kept going.”
Her inspiring journey, which began in Year 10, has taken eight years and was completed before her 25th birthday.
Beth Hilton mentored Kayla throughout the entire process.
“She was one of six who began the journey with me and the only one who completed the Gold Award. It’s been a privilege to walk this path with her,” she said.
“While there are lots of different programs at BDC that can help a student achieve this award, the process is student-led, with strong support from family, [which] develops independence.”

will soon accompany BDC Year 10 students on a Duke of Edinburgh Bronze-level Adventurous Journey to Washpool National Park.
As a certified Duke of Edinburgh Centre, BDC ensures that students receive safe, supported, and structured pathways to complete all levels of the Award.
The program is optional and is strongly supported and integrated into school life.
Various initiatives include volunteering at Op Shops, Soup Kitchens, and community service programs.
Tim Chapman, BDC Outdoor Education Coordinator and Duke of Edinburgh Leader, said, “the program complements our school values, introducing students to new skills, leadership opportunities and personal growth.”


11th October | 10am – 12pm
Domain Drive, Coffs Harbour










• Boutique community of 53 villas upon completion
• 2 and 3 bedroom designs with lock up garages
• Communal facilities including a heated swimming pool, BBQ area and gym
• Pet friendly


As an optometrist, having invested hundreds of thousands of dollars in quality equipment, it is our goal to use state-of-the-art technology and quality lenses to provide patients with the clearest, most comfortable and efficient vision to enable them to not only function efficiently but also to derive maximum pleasure from the beautiful world around us.
We have come a long way since rudimentary spectacles were first invented in northern Italy in the 13th century to correct presbyopia, a condition which affects the ability to read after the age of 40. The first spectacles to correct shortsightedness were invented in the 15th century in Germany, with the first bifocals invented by Benjamin Franklin in the USA in the 18th century and spectacles to correct astigmatism in the 19th century. Progressive lenses were developed in the 20th century in England.
Since then, billions of dollars have been spent improving the optical quality of lenses to the point that near natural vision can be restored for the majority of focusing errors. Paradoxically the quality of vision for a significant percentage of the Australian population has declined considerably, especially since “reading magnifiers” (which equate to the primitive spectacles of the 13th century) have returned to the market through sales in pharmacies, supermarkets and service stations. Reading magnifiers are a ‘one size fits all’ and don’t necessarily cater for the individual’s visual specific requirements.
If you’ve ever lost or forgotten your spectacles, you’ll have a true appreciation for the technology which allows us to have clear vision just by putting on your spectacles.
Our goal is to provide patients who “Value their Vision” with a quality service to ensure you not only get high quality lenses to maximise your natural eyesight, but we also take the time to provide expert frame selection, customised lens design, and frame fitting which are essential to maximise the performance of the lenses.
72 Albany Street
Coffs Harbour 2450
Phone: (02) 6652 7411
Scan the QR Code for Our Website alanburrow.com.au

By Andrea FERRARI
NEW chess tables made by the youth of Bellingen have been installed in the town’s Church Street.
The original “chessies”, as they were known locally, were removed by Council in response to vandalism.
The teams that brought the tables project to fruition were from the Bellingen Youth Hub, local police, Bellingen Shire Council and local businesses.
The project began as part of the 2023 YOUth Speak program developed and facilitated by the Neighbourhood Centres of Bellingen Shire.
It included a series of forums and surveys that consulted hundreds of teenagers from across the Shire.
The findings revealed a desire for young people to create their own safe and inclusive spaces.
The chess tables project was steered by passionate local teenagers, including 18-yearold Willa Herron, who played integral roles in conversations with Council.
‘’We had the previous Deputy Mayor Ellie Tree come to our school and sit with a group of us, [which is] where we decided that the chess tables needed to be re-instated,” she said.
“The previous tables had provided an undercover space out of the rain, to chill… and to always find at least one other young person.
“A group of my friends and I presented the
q The teamwork involved in installing new chess tables on Church Street, Bello.

idea to important members of the community, like Mayor Steve Allan.
“We spoke to him about how we didn’t want the chess tables to just be taken away.”
While the original tables had previously fallen into disrepair, preserving their long history in the town and reinvigorating them as a place for generations of teenagers to gather and share each other’s company was something the young people involved were


FRIDAY SHAKEDOWN STAGE 10TH OCTOBER 2025 8AM-12PM WEDDING BELLS FOREST - ROADS - FLOODED GUMS, BRUSH BOX, LANTANA.
SATURDAY 11TH OCTOBER 2025
7AM-6PM LOWER BUCCA, ORARA EAST FORESTS ROADS - KINGS RIDGE, FINBERG, LOOP, MCRAES, EAST BANK FOREST, KOOKABURRA, COTTAGE, LOST HUT TRAIL, PLONK, STORE, APSEYS.
7AM - 11:30PM WEDDING BELLS, CONGLOMERATE FORESTS ROADS - SHERWOOD, MCIVERS, MARY’S WATERHOLE, BRUSH BOX, LANTANA, TURPENTINE, FLOODED GUM, PLUM PUDDING, T TREE FOREST, KNOBBYS FOREST.
4PM - 11:30PM SHERWOOD CREEK ROAD BETWEEN MURPHYS RD AND PLUM PUDDING RD.








keen to do.
“It’s important that we were a part of the project because we are the people who use the space,” said Jet Hapgood, 17, a key member of the working team throughout the design and implementation phase.
The Bellingen Youth Hub’s Michael Mooney and colleague Kylie Selig were heavily involved in steering the project, facilitating the construction of the tables using the downstairs space of the Youth Hub as a workshop.
Hub volunteer Steven Denshire led the construction sessions, supporting young people to build the tables themselves.
“The project is a symbol of what can happen when we come together and work together towards an aligned goal,” Mr Mooney said.
“I am so thrilled with how much support came from the community, from the generous financial donation from Kombu Wholefoods, and support from other businesses like IGA and Zaatar who provided us with food and drinks to fuel the hard work.
“Bellingen High School also stepped in with support, helping to make the rebuild a true community-wide effort.”
Youth Hub staff are currently in conversations with businesses along Church Street, who are planning on storing sets of chess pieces for locals and visitors to use on the new tables.
Kombu Wholefoods owner Kevin Doyle, attended the installation of the table having provided key funding and ongoing support for the project.
“Our young people need to feel like they are being heard,” Mr Doyle said.
“They need to have spaces in town where they feel comfortable and proud of where they live.”

By Andrea FERRARI
"SHARE the shore" is Bellingen Shire Council’s message to the community now that shorebird season has arrived, with local and migratory birds flocking to the coastline to rest, feed, nest and raise their chicks.
Four species of shorebirds are known to breed within the Shire: The Pied Oystercatcher (endangered), Sooty Oystercatcher (vulnerable), Little Tern (endangered) and the critically endangered Beach Stone-Curlew.
Urunga Island is fortunate to host one of the 15 breeding pairs of Beach Stone-Curlews remaining in NSW.
In late August, Council’s River and Biodiversity
Officer and Environmental Education Trainee Celeste Lymn joined ecologists on the island to install new signage following sightings of shorebirds showing nesting behaviour.
During the visit, they observed several significant species, including beach stone curlew, pied oystercatcher, sooty oystercatcher, eastern curlew (critically endangered) and bar-tailed godwits (near threatened).
Since then, confirmed nesting sites with eggs have been located and fenced to reduce disturbance.
Additional nesting areas have been identified along the coast, with more signage now in place.

Council staff involved in the work described the discovery of nests and eggs as “elating” and are urging beach users to respect the signage and give the birds space to raise their chicks.
These species are highly sensitive to disturbance and can easily be scared away by humans, dogs, campfires and four-wheel drives near nesting sites.
This year marks the first time studies of this kind have been conducted in the Bellingen Shire.
While still in its early stages, the program is already providing valuable data on nesting sites, suitable habitat and potential impacts to shorebird populations.
The two-year study aims
to establish a clear picture of which species are using the local coastline to breed, and to guide Council and regional partners in strengthening protection of these critical habitats.
“So far, it’s encouraging to see shorebirds nesting and laying eggs in some areas, but they are highly vulnerable to disturbance and need to be given space to hatch and raise their chicks,”
Mayor Steve Allan told News Of The Area.
“Many people don’t realise how easily nests can be disrupted, even something as simple as letting a dog run through the area or walking too close to the birds can affect their breeding success.
“We urge everyone to


q The
respect the signage and keep well away from these sensitive areas.
“If you find a sick or injured bird, please report it to WIRES.”
Alongside the study, the Council is hosting a series of educational events.
Recently, community members attended a “Dog’s Breakfast” at Hungry Head, where National Parks and Wildlife Discovery Ranger Andrew Turbill led discussions on resident and migratory threatened shorebirds.
According to Bird Life Australia, some migratory shorebird populations have
By Rachel JACKSON, AAP
MORE than 200 people are being cut from a state's top regional agency in what unions say is a short-sighted budgetary surrender.
The move will come at a cost to research,
recovery and biosecurity for regional communities, according to the NSW state public sector union.
"This (NSW) government can no longer claim it supports the various research stations across the state," the Public Service Association said in a statement on Friday.
"These locations are being left to die on the vine."
The NSW Department of Primary Industries and Regional Development is set to axe 228 frontline staff, according to the
union statement.
The figure marks an increase from previous estimates that 165 jobs would be cut, a four percent workforce reduction.
A need to reduce staff numbers was foreshadowed by NSW Agriculture Minister Tara Moriarty in a February budget estimates hearing.
The "coward cuts" go much deeper than initially thought, NSW Nationals Leader Dugald Saunders said on Friday.
"This decision is not
just reducing a headcount but taking away years of knowledge and experience across a range of fields," he said.
"It feels like once again the premier and the agriculture minister have been keeping secrets about the swift removal of these employees, and the diabolical impact it will have on frontline services across regional NSW."
Many of the staff to go are older than 55 and have worked with the agency for more than two decades.
Affected staff will
be able to apply for 96 proposed DPIRD roles, and some will be provided pathways to seek other public sector jobs.
Unions previously proposed the agency cut staff from senior service, or the 655 temporary workers employed by affected divisions.
The department acted as a standalone agency before a major restructure in 2024, branded by opposition MPs as a plan for "regional ruin".
Premier Chris Minns said the changes were part
declined by up to 80 percent in the past 30 years.
These remarkable birds travel more than 10,000 kilometres from the Northern Hemisphere to spend their non-breeding season in Australia.
The Mid North Coast coastline provides them with critical habitat to rest, feed and build the energy needed for their return journey.
“The message is simple: the signage is there for a reason.
“Respecting it helps protect some of our most vulnerable coastal bird species at a critical stage in their life cycle.”
of the state government's commitment to regional NSW.
The NSW Department of Primary Industries and Regional Development was contacted for comment.

By Andrea FERRARI
COFFS Harbour City Orchestra will take its audience on a maritime adventure during its concert in Nambucca Arts and Community Centre on Sunday 19 October.
The program provides a selection of music from various time periods and maritime themes, from a pleasant gondola trip down a Viennese Canal in the Barcarolle; a tragic love story in selections from the movie Titanic; riding waves of adventures and mischief with selections from the Pirates of the Caribbean
movies; and the well-known Water Music that Handel wrote for an orchestra travelling down the Thames on a barge.
Coffs Harbour City Orchestra spokesperson Cathie McIntyre said one of the highlights of the concert will be Edward McKnight’s “Hold Fast”.
The music’s inspiration comes from when sailors were instructed to "hold fast" during a storm, meaning “hold tight, hang on, and secure the ropes and the rigging”.
“We believe our orchestra will be the third group to perform it.”
The orchestra’s Artistic Director Tim Egan, often provides information on the music played and the sounds of instruments to educate audiences.
He says that audience members will enjoy the variety presented at this concert and that Nambucca Heads is the perfect place to present a nautical themed concert.
The orchestra will host afternoon tea after the concert.
On the previous day, Saturday 18 October, the orchestra will play a free concert to the residents of Shoreline in Coffs Harbour.









By Andrea FERRARI
THE Coffs Harbour Neighbourhood Centre (CHNC) is running Round
3 of its successful, fee-free Digital Sisters program; an initiative aimed at bridging the digital divide for women from migrant and refugee
backgrounds in the Coffs Coast region. Funded by the Good Things Foundation Australia, the program is part of CHNC’s broader commitment to social inclusion, digital equity, and multicultural empowerment.
Through its first two courses, the Digital Sisters
program has already supported over 80 local women in building confidence and skills in using digital devices, accessing online services, and connecting safely in the digital world.
For many participants, the workshops have meant more than just learning to use

a smartphone or navigate the internet, it has been a gateway to greater independence, confidence, and connection to community life.
“This program is about more than just technology,” said program coordinator Lauren Mills.
“It’s about empowering women to feel capable and confident in a digital world, whether that's using MyGov (website and app), communicating with schools, or staying in touch with loved ones overseas.
“And these skills are being taught in the learner’s first language.”
The Digital Sisters Round 3 format is a series of free digital literacy workshops offered in the Yazidi language, specifically for Kurdish Kurmanji-speaking women in the Coffs Harbour area.
This new initiative comes in response to community feedback and the growing Yazidi population who have resettled in the region.
Many of these women face unique barriers to
digital access due to limited English proficiency, trauma backgrounds, and lack of prior exposure to technology, said Ms Mills.
The Yazidi-language sessions will be delivered by trusted bilingual female community mentors from the Yazidi community, ensuring that participants can learn in a culturally safe and linguistically appropriate environment.
Topics include basic smartphone use and online safety, email tips and tricks, using translation tools and communication apps including AI, and accessing community services and emergency information.
The success of Digital Sisters lies in its communityled, trauma-informed approach.
Each workshop is designed to be welcoming and flexible, accommodating women with childcare responsibilities and varying literacy levels.
Workshops are held in the welcoming Coffs Harbour
By Andrea FERRARI
RALEIGH Urunga Masonic Village Lifestyle Supervisor, Kristie Payne, has been named Mentor of the Year in the Royal Freemasons’ Benevolent Institution (RFBI) 2025 annual Showcase Awards.
The program recognises the outstanding efforts of staff and volunteers from across the organisation in seven categories.
The accolade bestowed upon Kristie is testament to her unwavering commitment to compassionate and personcentred care, as well as her exceptional leadership skills.
A valued member of the
team at RFBI Raleigh Urunga Masonic Village since 2018, Kristie has consistently demonstrated a natural ability to lead, support, and inspire both individuals and teams across the organisation.
Her approach to mentorship is characterised by a deep sense of empathy and understanding, ensuring that every team member feels valued and supported.
This award recognises her ability to foster a positive and inclusive environment where everyone can thrive.
“Being able to support, inform and sometimes even inspire residents keeps me engaged and committed,” Kristie told News Of The Area.


“I enjoy knowing that the support I give to residents can improve their day, whether it’s through having a simple conversation, encouraging them to do the things they love or helping them live their best life.
“The little things we do each day often mean the most and I find that really rewarding.
“I enjoy being part of a team that supports residents to live with dignity and comfort.
“I also enjoy sharing my knowledge with other team members and mentoring
q Chief of Operations - Residential Care Sanjila Verma and Chief of Operations - Seniors Living and Quality Louanne Riboldi, present Kristie Payne with her award.
Neighbourhood Centre’s large meeting room, with language support and digital mentors who understand the lived experiences of participants.
Previous participants have reported significant improvements in their ability to engage with online services, help their children with school, and even apply for work or training opportunities independently.
“Before this program, I was scared to email,” a past participant said.
“Now I can email my children’s school and use MyGov online.”
The Digital Sisters Yazidilanguage digital literacy workshops will begin with the first block of lessons starting on 15 October at the Coffs Harbour Neighbourhood Centre.
Interested women are encouraged to register early, every participant will receive a certificate after attending two sessions and gain access to further online learning.
For more information or to register, contact the Coffs Harbour Neighbourhood Centre on (02) 6648 3694 or email lauren@chnc.com.au.
them, it is another part of my role that I am dedicated to.”
What drives Kristie’s compassionate commitment every day is knowing that the care she provides helps residents feel comfortable, safe and respected.
“The personal connections I make with residents and families gives every day a sense of purpose.
“A smile, a thank you, or simply being there for someone reminds me why I do this work.”
Winners were announced at RFBI’s Showcase Award Night at the Sydney Masonic Centre on Tuesday 23 September.
RFBI was founded in 1880 to assist people in need.
It is a not-for-profit aged care provider operating 22 residential care villages, 20 retirement villages and offering a range of home care services across NSW and the ACT.

WESTSIDE Tennis Club will receive $28,500 from the City of Coffs Harbour for the refurbishment of four pickleball courts on the hardcourt tennis court.
The club is one of seven organisations successful in the City’s Community Infrastructure Renewal Grants Program.
With $150,000 allocated
to this program in the current financial year, applications for support were opened to not-for-profit organisations seeking to construct new public facilities or to refurbish

existing infrastructure on City-owned or managed land.
“This is all about improving facilities where the work will bring direct benefit to the wider community,”
Mayor Nikki Williams said.
“It is great to see such a diverse range of projects successful after an assessment process.”
Acting General Manager Andrew Beswick said renewal projects are prioritised over new capital works in line with the assessment criteria.
“All up, 12 submissions were received in a competitive process, and the applications were tested against criteria outlined in the City’s Community Funding policy and guidelines,” Mr Beswick said.
“Some applicants received less than what they
THE Bush Fire Danger Period (BFDP) began on the Coffs Coast and across the broader North Coast on 1 October.
Rural Fire Service (RFS) Superintendent Sandra Huer said following several wet years, fuel loads remain high across the state and the risk of serious bush and grass fires is returning.
“Now is the time to review your plans, prepare
your properties and have the conversation with your family about what you will do during a fire,” Supt Huer said.
“Having a bush fire survival plan will ensure all members of the household know what to do on days of increased fire danger and what actions to take should a fire threaten your home.”
Supt Huer said while the RFS is doing everything it
can to mitigate the risk of fire, preparation is a shared responsibility and property owners need to do their part too.
“Worryingly, recent research tells us less than half of residents living in bush fire prone areas have undertaken any preparatory work on their properties,” Supt Huer said.
prepare their property by removing flammable materials from their yards, clearing leaves from gutters, checking hoses can reach all around the house and where appropriate, conducting hazard reduction activities.”
During the BFDP, landowners and managers are required to obtain a Fire Permit.
were requesting, but this put the City in a position to support more projects.”
At its meeting of 25 September, Council resolved to endorse funding for the following initiatives:
• Autism Spectrum Australia (Aspect) - $20,500 for ‘Shelter and Shade for Aspect Macarthur students in Coffs Harbour’, installation of a permanent all-weather shelter
• Coffs Regional Community Gardens Association Inc - $13,488 for ‘Replacement of solar panels, batteries and inverter’, replacement of existing 1.4kw solar system with a 5kw solar system
• Early Connections - Coffs Coast - $30,000 for ‘Roof Restoration ProjectStage 2’, restoration of roof on western side of the centre
by applying online or by contacting the local Fire Control Centre before lighting any fires, including hazard reduction and pile burns.
“While hazard reductions are an important part of preparations, landholders need to be extremely careful, as escaped burns can lead to heavy penalties,” Supt Huer said.
• Mountain Community Network Inc - $18,300 for ‘CPR for Lowanna Community First Responders Shed’, renovation of the First Responders’ shed to improve ventilation
• NSW Basketball Association Ltd - $33,200 for ‘Sportz Central Heat Relief Project - Stage One’, renewal of cooling systems with installation of ceiling fans in Hall 2
• Sawtell Tennis Club Inc - $6,000 for ‘After the Storm: Fence Reborn’, refurbishment of damaged fencing on courts 10 and 11; and
• Westside Tennis Club Inc - $28,500 for ‘Project Pickle - The Coffs Coast First Purpose Built Pickleball Courts’, refurbishment of four pickleball courts on the hardcourt tennis court. that conditions allow for safe burning and you have the necessary precautions in place.
“If a fire does escape, make sure you call Triple Zero (000) immediately so that emergency services can respond and minimise the damage.”
This can be obtained
By Andrea FERRARI
KEY Employment will continue delivering disability employment services under the new Inclusive Employment Australia program, starting 1 November.
Inclusive Employment Australia is the Australian Government’s new specialist disability employment program.
It replaces the Disability Employment Services program.
A long-standing local organisation, Key is one of the largest disability and community services on the Mid North Coast.
It delivers inclusive employment support from Yamba to Kempsey, and is expanding into Port Macquarie, Taree and surrounding areas.
“This is the continuation of something Key has been deeply committed to for over 30 years,” CEO Jodi Wood said.
“Since 1991, our mission has always been simple: to help people with a disability find meaningful, open employment.
“We started as a small, family-run organisation with a big heart, and even as we
grow, we’ve never lost that community-first spirit.
“We’re incredibly proud of our team and what this milestone means for the thousands of people we’ll now have the privilege to support.”
Inclusion is fundamental to the fabric of the organisation and continues to guide the way Key walks alongside participants.
Nearly a third of staff identify as having a disability,
“Residents should and participant steering committees operate across all sites to ensure lived experience shapes every decision.
“I’ve been a participant with Key in the past and have now been working here for more than two years,” Chair of the Coffs Harbour Participant Steering Committee Kym Lindsay said.
“I can honestly say this is a place where people with a disability are listened to,
respected and supported to succeed.”
Key also acknowledged the providers exiting the sector, who have supported people with disability across the Mid North Coast for many years.
“We know this change may feel overwhelming and daunting for many in our community,” Ms Wood said.
“We want to recognise the commitment of the providers who are leaving the sector

“Before you light a fire, it’s critical that you check and reassure our community that we are committed to ensuring a warm, supportive, and empowering transition for everyone.”
Key has started hosting community BBQs and open days across all locations.
These events are a chance to meet the team, ask questions, and learn more about the services now available.
“If you’re feeling unsure or overwhelmed by the
Information about hazard reduction burning and required notifications is available on the RFS website at www.rfs.nsw.gov.au/fireinformation/BFDP. changes, please don’t hesitate to reach out.
“Give us a call on 1300 539 562 or drop into any of our offices, we’re here to listen, to help, and to make sure you feel supported every step of the way."
Visit keycommunity group.com. au or follow Key Community Group on Facebook, LinkedIn or Instagram for updates.

ON Thursday 9 October, the City of Coffs Harbour’s Jetty Memorial Theatre will host a special encore screening of “The Great White Whale”, Michael Dillon’s extraordinary film chronicling one of the boldest adventure stories of the 20th century.
Far out in the Southern Ocean, between Australia and South Africa, lies Heard Island, an isolated, glacierclad volcano that rises almost 3000 metres from the sea like a mythical beast.
In the 1960s, legendary explorer Bill Tilman led a crew of sailors and climbers in their audacious bid to reach its summit. Five times the mountain tried to defeat them, yet they returned, their resilience becoming the stuff of legend.
Dillon’s film captures the beauty and peril of this remote place, combining original expedition footage, the humour and grit of the team and a sense of wonder at the untamed world.
At its heart is a reminder of the courage that drives people to test themselves against the unknown.

Following the screening, audiences will have the opportunity to hear from Paul Jarman, the composer behind the film’s unforgettable soundtrack.
A resident of Valla, Jarman
is an acclaimed composer, conductor and performer.
His career spans over 300 commissioned works, collaborations with leading ensembles worldwide, and compositions performed at
Want to get your business in front of an audience that’s actively looking for things to do, places to go, and experiences to enjoy?
Our What’s Vibin page is one of the most read sections of the newspaper — the perfect place to showcase your brand, promote your events, or drive traffic to your location.
TARGETED EXPOSURE –
Reach readers who are interested in dining, events, nightlife, movies, local attractions, and more.
HIGH ENGAGEMENT –
Entertainment content naturally draws attention, meaning your ad gets seen.
PERFECT TIMING – Our readers use this page to plan their weekends and free time.
LOCAL IMPACT – Position your business as part of the community’s go-to guide for fun and entertainment.

Whether you’re promoting a restaurant, event, service, or product — advertising in What’s Vibin connects you with the right audience at the right moment.
Let us help your business stand out. Contact us today to learn about ad sizes, pricing, and special packages!
landmark events including the White House, the Rugby World Cup and the United Nations Year of the Mountain. Paul has also been a frequent collaborator with Michael Dillon, bringing
depth and resonance to his films.
An adventure on screen, and in conversation, not to be missed.
Tickets available at jettytheatre.com.
This special evening offers the chance to witness a rarely told chapter of Australian exploration and to gain insight into the artistry that shapes how such epic tales are remembered.



Contact us for more information. ads@newsofthearea.com.au 02 4981 8882



SatURDAY 11 OCTOber
10am-1pm
Yarrila Place, 27 Gordon Street
Explore Yarrila Arts and Museum, visit Harry Bailey Memorial Library, grab a free bell for your bike, and venture out with the Coffs City Centre art trail on the Coffs Coast Explorer App.
Amazing new art exhibitions | Art making activities | DJ Salty spinning tracks & taking requests | Bells for bikes | Games galore STEAM activities | Giveaways | Citizen Science Corner activities | Student animation showcase Peach & Wolf open | Coffs City Centre art trail | and so much more!































By Manny WOOD
HELENA lived on her rural property for decades with her partner, Lionel.
Together, they worked the land and built their home.
When Lionel’s health declined, Helena took on the role of his full-time carer.
A combination of caring duties, Lionel’s advancing age and her constant worry over finances left Helena exhausted and struggling to keep up with the payment of expenses.
When Lionel passed away, Helena became the sole owner of the property.
With no children and few surviving relatives, Helena was left to face everything on her own.
At that time, two friends and neighbours, Stephen and his wife Mariette, stepped in with what they presented as a solution. They drafted an agreement which said that in exchange for covering some repayments and expenses and assisting with some maintenance on the property, they would gain an immediate one-third interest in the property and the whole property after Helena’s death.
Helena recalled signing the document under financial strain and without proper legal advice.
What was framed as help with debts, in reality, tied up her most valuable asset and threatened to undermine the estate she intended to leave to her relatives.
When Helena later updated her Will, she included the property, intending it to be part of her estate.
Stephen and Mariette sought to enforce the agreement with the effect that the property would never form part of Helena’s estate, effectively contradicting her Will.
The Court found the agreement to be heavily one-sided.
The contributions Stephen and Mariette promised were modest compared to the benefit they were gaining.
The Court held that the agreement was unconscionable, given Helena’s age, financial stress and lack of advice when the agreement was signed.
The Court also pointed to the Contracts Review Act, which gives the Court the right to refuse to enforce agreements that are unjust.
On that basis, the agreement was set aside, the Woolgoolga property was confirmed to form part of Helena’s estate and would be distributed in line with her Will.
Thank you to Ellysha Laklem, for her assistance with this column.
This fictional column is not legal advice.

Let’s not be driven by fear and division
LAST week the Nambucca Valley Council rescinded an original resolution from 2018 to not support the Great Koala National Park (GKNP).
This now gives the Council an avenue to explore the economic and environmental opportunities provided by the State Government announcement of the GKNP, an election promise, for our local community.
As a community representative I think it’s important for me to emphasise why I support exploring the opportunities presented by the GKNP, whilst also emphasising the role of Council in supporting the transition of businesses and employees from the timber industry.
Change is always challenging, and I for one do not believe in change for the sake of change – rather, I believe in change to achieve a better outcome.
I believe in our sustainable future.
The strong economic proposition to lobby for funding from the NSW Government in boosting agritourism, eco-tourism and Indigenous eco-tourism from the GKNP project cannot be overstated.
I do not support continued negativity which puts our economic and environmental future at risk.
“This is not a debate about climate or conservation, it’s about fairness and commonsense,” a recent media release from the State MPs of Oxley and Coffs Harbour said.
The recent media releases by several state MPs across the NSW Mid North Coast in response to the Great Koala National Park announcement are a great example of misinformed debate and deflection of criticism.
I guess I do fail to see commonsense when we as a species seem hell bent on destroying our own habitat and ecosystem at
a rate which is not sustainable.
Most people would not know that 91 percent of the timber industry in NSW already comes from plantation timber with the remaining nine percent harvested from our native state forests.
And here’s the clincher – native forests in NSW were harvested at a $29 million loss and cost to the public in 2023-24 financial year alone.
The economic argument just doesn’t stack up.
And no, regrowth forest monocultures are not as fire-hardy as older multi-species forest.
And no, the animals who lose their habitat do not re-establish other habitats.
In fact, Australia is the only developed country on the global list of deforestation hotspots, with 40 percent of our forests destroyed since European settlement and with one of the highest species extinction rates in the world (Joint Statement, KunmingMontreal Global Biodiversity Framework).
Independent peer-reviewed scientific research shows that the economic value of water catchment and tourism in native forests are respectively 25 and 20 times greater than the commercial value of woodchips, paper pulp and timber from native forests.
And the value of the plantation products is three times greater than the value of the native forest area products.
The economic proposition of switching away from native forest logging to 100 percent plantation forest appears to be a no-brainer.
Put simply, forests purify our drinking water.
Forests are our best hope to reduce carbon emissions.
Forests and water are life.
And we have the opportunity to walk the talk on our commitment to build a thriving economy which is sensitive to our environment and lifestyle.
Let’s not be driven by fear and division but

Email Jasminda: media@newsofthearea.com.au
DEAR
Jasminda,
I've told my husband he is sometimes insensitive in his responses, but he doesn't seem to be able to change. Do you have any suggestions? He's great in every other respect.
Claudia Q.
Dear
Claudia,
Firstly, I offer my condolences regarding your husband's occasional insensitivity.
People can be brash or unthinking at times and it can be hard to handle.
Perhaps you could suggest to your husband that he run his responses through AI.
For example, imagine you are about to go out and you've put on some makeup at which point your husband says something like: 'What have you done to your face?'
Now, if he'd run that through AI, it would have given him a few more palatable options, such as, and I quote: 'Oh, you look different. Did you try something new with your makeup?' or … 'You did something with your makeup today, right? It's bold. Tell me about it' or … ‘Oh honey, you did not come to play -- you came to slay. I see it. I fear it. I support it.' These responses could (potentially) make you feel better, but maybe not. In fact if my husband replied with any of the above AI responses, I'd probably think he was having an affair. Not just any affair, but an affair with the lovechild of Liza Minnelli and Liberace.
It would also mean toning back on the usual retort, such as, 'At least I didn't brush my hair with the leg of a chair' or 'Mmmm. Shorts and boots. Interesting.'
Without concrete examples from you, it's hard for me to offer a more specific solution, but I've always found a withering stare is particularly effective in many situations.
Sometimes the less said, the better.
That may be a good message for your husband too.
Carpe diem, Jasminda.
work together for our sustainable future. Regards, Dr Ljubov SIMSON, Councillor, Nambucca Valley Council.
DEAR News Of The Area,
IN response to "Farmers slam government over banana import review", 26/9.
The Australian Banana Growers Council stated that imports of bananas are unnecessary and risky, so what is the real agenda of the Federal Government? Is it to placate foreign business and
political stakeholders, to undermine the power of local farmers to be beholden to those who only care about profit, potentially ruining livelihoods and communities?
To local growers, you have my support if imports are ever permitted.
I will exercise my right not to purchase any foreign bananas and encourage other consumers and businesses to also act in the
interests of local farmers and the people who rely on the industry for their livelihood. Regards, Zoe DEFTEROS, Coffs Harbour.
DEAR News Of The Area,
AUSTRALIANS quite rightly believe that there is no place for antisemitism in this country, and I am sure that many rightthinking people will be moved to join a movement to resist, schooled as we are in the horrors of the Holocaust (‘Never Again is Now in Coffs Harbour’, NOTA Letters, 26 September).
Movements like the Never Again is Now (NAIN) group recently formed in Coffs Harbour usually exist to pressure the government but the Albanese government gives wholehearted support
to any targeted group.
When the attacks on schools and synagogues earlier this year were found to be perpetrated by thugs in the pay of Iran, the Iranian ambassador was promptly expelled.
After this the Prime Minister appointed Jillian Segal as envoy to combat antisemitism in Australia but has since remained quiet on the report.
For one organisation to recommend the defunding of universities that fail to reduce hatred, monitoring media organisations to ensure accurate coverage, and screening visa applicants for antisemitic views is a
step too far for many Australians.
We are a country which has given, and continues to give, refuge to many different racial and religious groups.
NAIN stands for traditional family values such as faith, family, community and country and I am yet to find these values missing in any of the communities who shelter here.
All parents seek for their children a safe place to live, to be educated, to practise their faith in peace, and to be a part of the community in which they have landed.
Acknowledgement of the situation in
By Karen FILEWOOD
BOARDING houses and flats were numerous in Coffs Harbour during the early 1900s, especially in the jetty area.
As the region’s transport hub for shipping and the railway, many travellers, tourists and workers were to be found, all requiring lodgings.
One family offering accommodation in the form of furnished rooms and flats, for short or long-term stays, was Mr and Mrs Harden.
Henry Harden was the seventh of ten children born to shipping company manager, John Harden and his wife Susan on 1 August 1848, in the suburb of Raheny, in Dublin.
The family divided their time between their home at Dublin Port and the Harden ancestral family home in Raheny, both not far from the sea.
Henry immigrated to Australia around the 1870s, becoming a police sergeant in Queensland, then customs
work in Brisbane, before taking up farming at Tintenbar, near Ballina.
While living there, he met and married schoolteacher Miriam Everingham, a cousin of well-known Coffs Harbour undertaker, Claude Everingham.
In 1906 the couple and their children moved to Lower Bucca and continued farming, then twenty years later, probably to cater for their retirement from farm work, Henry and Miriam opened accommodation in Coffs Harbour’s jetty area.
This was first advertised in the local paper during July 1926 as furnished
DEAR News Of The Area,
LAST Thursday evening, members of the Little Arrawarra community attended the Council meeting where councillors unanimously voted in favour of a feasibility study to improve public beach access.
For more than 20 years, this issue has
been raised, debated, and deferred, but never before has it reached this point of real progress.
Our community is both thankful and supportive of this next step, which represents a milestone in ensuring safe and legal access to one of the region’s most beautiful natural assets.
Little Arrawarra’s beach is something we are deeply proud of.
We want both residents and visitors to enjoy it, but the current situation makes access difficult and, in many cases, dangerous.
For too long, safe and legal access has been an unresolved challenge.
Gaza is strangely missing from both Jillian Segal and Alison Buckley, even though an Israeli presence is evident in Australian pro-Palestinian rallies.
I would be very cautious about aligning myself with an organisation which appears to overlook the multiple crimes against humanity inflicted on innocent civilians by the current Prime Minister of Israel. Our present laws against hate crimes are sufficient for the Australian people of all racial and faith groupings.
Anything else has the potential for division.
Regards, Margaret ENGLAND, Toormina.
rooms or flats in a ‘beautiful position overlooking ocean, for moderate rent’, with applications to Mrs Harden.
These lodgings became a popular destination for tourists, longer-term residents and sometimes, hospital outpatients, while social gatherings had free use of empty rooms.
Henry died the following year however Miriam stayed on until she sold it in 1930.
Henry Harden’s ancestral home and birthplace was named ‘Brighton Lodge’ and he had named his Lower Bucca farm ‘Brighton Lodge’, while he called his jetty accommodation ‘Brighton Flats’.
In the meantime, his older brother had emigrated to New Zealand in 1879 to farm and after selling his property he built a residence in the port town of Whangārei, also calling it ‘Brighton Villa’.
This study signals the possibility of bridging that gap, so the beach can be enjoyed safely and responsibly by all.
We applaud the councillors for listening and taking action, and we look forward to seeing the outcomes of the study and the positive difference it can bring for locals and visitors alike.
Regards, Gina INGLEBY, Little Arrawarra.
dedication and passion of those working to protect our natural environment,”
By Andrea FERRARI
COFFS Harbour Regional
Landcare (CHRL) is calling on the community to help celebrate local environmental champions by nominating individuals, community organisations, businesses, or schools for the Pia Dollmann Memorial Conservation and Sustainability Community Award.
This award honours the legacy of Pia Dollmann by recognising individuals, community organisations, businesses, and schools that have made a meaningful impact through conservation and sustainability initiatives in the Coffs Harbour region.
Whether it's restoring bushland, leading school sustainability programs, rescuing wildlife, or creatively reusing waste this is the community’s chance to celebrate those making a real difference in the environment of the Coffs Coast.
“This award is a wonderful opportunity to highlight the
CHRL President Alison King said.
“We encourage everyone in the community to share the stories of those making a difference.
“Let’s celebrate the people and projects shaping a more sustainable future for Coffs Harbour.”
The judges look for nominees’ eligible activities which include bush regeneration and revegetation projects, waterway clean-up initiatives, school-led sustainability programs, community environmental education efforts, creative reuse and recycling of waste materials, citizen science and environmental monitoring, wildlife rescue and rehabilitation and climate change mitigation initiatives.
Last year’s winner Kris Hely exemplifies the qualities of the Pia Dollmann legacy award.

Described as a deeply committed conservationist who puts words into action and gives back far more than she is given, Ms Hely has volunteered and led a number of local Landcare sites over the years.
































Address: 24 Alexander Street, Nana Glen
Price: $1,090,000
Beds: 3, Bath: 2, Car: 2
Land size: 3,923.4 sqm
IMAGINE coming home to your own piece of rural paradise.
This charming threebedroom home, located in the historic Nana Glen village approximately 25km from Coffs Harbour, will please those looking for a private and picturesque lifestyle.
Striking rural views of the valley and surrounding

mountains make you feel like you are a million miles from anywhere, but still so close to all that Nana Glen has to offer, such as a general store with a post office, a café, school, swimming pool, and the Orara River swimming hole.
The property features beautiful blackbutt timber floorboards throughout the entry level of the country style home.
A shady front verandah wraps around to the right of the home leading to the rear entertaining deck with views
of the established gardens and mature trees that attract the native wildlife plus the valley and mountains beyond.
The cosy loungeroom features a wood fireplace, timber ceilings, and ceiling fan.
The tastefully renovated kitchen offers a reverse cycle air con unit, a white tiled splashback, stone benchtops, as well as double fridge space, electric oven and cooktop, plus a dishwasher.
Adjacent is the dining space which flows

seamlessly to the large rear covered outdoor entertaining area.
This is the perfect space to sit, relax and enjoy all year round, whether it's entertaining guests or just enjoying the peace and quiet of your rural retreat.
Also on the entry level there are two bedrooms, which are both queen size with built-in robes, and ceiling fans.
The exquisite main bathroom is also on this level.
Renovated a few years

ago, this bathroom is one of a kind.
You will adore the open shower with a picture window to enjoy the mountain views and your own incredible rear gardens and trees.
Head up the stairs to find vaulted ceilings that add to the country charm of the home.
The bathroom on the top floor facilitates this level acting like an ensuite for the extra-large main bedroom with walk-in/built-in robes.
The living space attached
to this level could be perfect for a parents retreat, second living area or a perfect office space. Also at the property is a garage space with laundry, workshop, double tandem carport, extra shedding, and under the house is a WC with sink. There are three water tanks, a septic trench system, plus a 4.5kw solar system to help with the power bills.
Agents: Kim McGinty (0432 953 796) and Chris Hines (0439 667 719).


By Andrea FERRARI
CELEBRATED Coffs Harbour
painter Seabastion Toast
has been voted the Sunshine Coast People’s Choice winner at the Caloundra Regional Gallery.
Toast’s winning painting, The River House, features fellow acclaimed Coffs Coast artist Karlee Rawkins, alongside her son and local model Raji Renshaw.
The portrait reflects the profound influence of motherhood on Rawkins’ artistic practice.
As the mother of a child with a disability, she has developed a deeply collaborative process that includes her son, her other children, and her partner.
Seen from a bird’s eye view, the painting captures Rawkins and her family in an intimate space, enveloped in rich patterns and fabrics reminiscent of Renaissance
ceiling frescoes.
The reclining figures appear in rhythmic harmony with their surroundings, treated with the same importance as the vibrant textiles that frame them.
“Painting Karlee and her family was one of the most fun, collaborative art adventures I have been on,” Toast told News Of The Area.
“Each member brought their own theatricality to the scene, and I could honestly make 100 paintings from that one experience.
“They embraced my ideas wholeheartedly and I was entranced by the abstract shapes as they moved across a ‘nest’ of fabrics, toys and other household objects.
“The whole photoshoot became a play where stories emerged through gestures and warm family interactions.
“The painting is oil on canvas, quite large at 120cm x 150cm, and took two months
to complete”.
Toast, who was also awarded People’s Choice in 2023, said the award is particularly meaningful because it is chosen by the community.
“As artists, popularity isn’t usually something we chase,” she said.
“So, to win People’s Choice for the second time makes me feel like I’ve found my people.”
She also paid tribute to the role of regional galleries.
“Every step into a regional gallery is a vote for beauty over despair, for community over division, for possibility over silence.
“That’s what people do by engaging with art.”
Alongside her exhibition practice, Toast runs monthly untutored portrait sessions at YAM (Yarrila Art Museum) and will present a solo exhibition at YAM in March 2026.


By Pauline CAIN
FOUR months after the devastating May floods on the Mid North Coast there is still a lot of work to do.
Susie George, Executive Director Regional Delivery with the NSW Reconstruction Authority, was on the ground in Nambucca Heads, Kempsey and Taree last week.
”The focus now is on getting out to people through a series of community events to make sure we don’t leave
anyone behind,” she said.
“We have been catching up with local councils and providing support with emergency works where we can.
“More than 14,500 residents have recently visited our recovery centres on the Mid North Coast and in the Hunter.
“Thirty-seven tonnes of waste has been cleared.
”Councils are working hard (in the flood recovery effort) and the
Reconstruction Authority have been supporting them with communication, transport and infrastructure.”
The recovery process is continuing to support individuals with rental assistance, home repair grants and a housing package which is facilitating accommodation options for farmers to remain on their properties.
“We are listening to feedback and are keen to help people who may still
need help to complete grant applications,” Ms George said.
“Some of these grants are still available until November.
“Recovery is a long and frustrating journey and some are only now coming forward for support.
“We want to make sure that each individual gets the support they requireso please make contact if you need extra help with grants or with mental health support.”
By Andrea FERRARI
THE South Coffs Community Garden (SCCG) has received a $15,632 NSW Government grant under the 2025 Community Building Partnership program.
Member for Coffs Harbour Gurmesh Singh said the grant will enable the Community Garden to install a freestanding polycarbonate greenhouse to allow year-round production of seedlings, cuttings and plants.
In its grant application, the SCCG reported that the members were “severely restricted” by their current greenhouse due to capacity, climate and water problems.
The purchase of a new greenhouse will allow an all-weather/allyear operation, greatly increasing production capacity, variety and an extended seasonal range.
It allows for greater inclusion of the community while introducing and
encouraging sustainable practices, SCCG President/ Treasurer John Higgins told News Of The Area.
“And it improves members’ access to seasonal material for their rented plots to supply sustainable organic food for their families.”
“[It also means] easing the cost-of-living crisis for community members by growing their own produce; enhanced health benefits to all participants from increased outdoor activity; the related nutritional benefits from producing and consuming locally grown organic plants; and increased membership of the Garden, allowing more community members to participate in the physical and mental health benefits of an outdoor activity… with social interaction.”
SCCG provides locally grown organic produce and low-carbon miles seedlings, cuttings and plants to the local community on the first Wednesday of each

By Andrea FERRARI
VIVIAN Simpson is speaking out to promote the personal benefits of volunteering.
The recent recipient of a Medal of the Order of Australia (OAM) in recognition of his community service, Mr Simpson has been involved with Sawtell Catholic Care, providing aged care; Coffs Harbour Salvation Army, providing welfare and emergency services; the Federal Government’s community visitors scheme, working out of the Coffs Harbour community village; and private home care.
He was also a finalist in Ageing Australia’s “You
are ACE!” award, a program that recognises excellence in aged care.
“Doing community service or volunteering can be done in many capacities,” he told News Of The Area.
“You can use your life or trade skills to make a difference in the community that you live in… and it’s good for one’s own mental health wellbeing.”
For Mr Simpson, the reward can be the simple gesture of seeing a smile on someone’s face because of something he has done for them.
“Taking people with disabilities to church mass, which is a very important
part of their lives, makes me feel I have contributed to their wellbeing,” he said.
Volunteering in aged care began for Mr Simpson when his mother became a resident in an aged care facility.
Through visiting her each day, he saw that there were many residents that either did not have family, or their family lived too far away to visit regularly.
“I enjoyed talking to these people and sharing their life stories, voluntarily becoming their visitor too.”
Mr Simpson volunteered with the Salvos for many years.
This led to him becoming
involved in the organisation’s disaster relief work - cooking in evacuation centres during bushfires and floods.
“I recommend people try different types of volunteering in areas you are interested in or are passionate about.
“For example, if you like gardening, the Friends of the Botanic Garden are always looking for volunteers, as are the Pink Ladies (at the hospital) and the RSPCA.
“The Community Village also has a volunteer centre where they will find you volunteer positions that will give you personal satisfaction and the ability to use your skills and interests.”
By Kim SATCHELL
THE issues around mental health are complex and
accessing the appropriate services can be difficult to navigate in a stressful situation.
The problem is exacerbated in rural and regional areas where suicide rates are higher but available

resources are lower than in metropolitan areas.
The founders of The Wellbeing Network, Jason and Davina Warman, who are based in the Clarence Valley, have had to deal with their own share of adversity and parental stress in the face of mental health issues.
From lived experience, and backgrounds in allied health, communications and business, they understand the internal and external pressures rural and regional families are facing in the midst of economic hardship, natural disaster, housing affordability and rising living costs.
The vision they are

pursuing on the North and Mid-North Coast (aimed at the whole of Regional Australia) entails creating mental health support in the form of travelling, stigmafree wellbeing hubs.
These would provide access to cost-free care through connection to a network of services - clinical, complementary, digital, social and communitybased.
Co-founder Davina told News Of The Area that, “the aim is to be Australia’s leading travelling mental health outreach provider, helping people take action early, reducing pressure on emergency services, and strengthening local communities”.
“A mobile walk-in bus bringing support directly to
you, access to mental health workers, peer support, private telehealth stations, online programs, local professionals, classes and community groups [with] no appointment, referral or Medicare required.”
The values that underpin this initiative to drive change are: humanity first (respect for individuals), access for all (quality care made available), wholeperson healing (multifaceted response), livedexperience leads (situated learning), community-led change (empowering local people) and courage to act (building what is needed).
To learn more about the Wellbeing Network, go to the website at thewellbeingnetwork.org. au.
COMMUNITIES across
NSW are being asked which towns and specific locations should be commemorated with a blue plaque to create a Freedom Ride Blue Plaque Trail, honouring a significant chapter in Australia’s civil rights movement.
The 1965 Freedom Ride brought national attention to racial injustice and discrimination against Aboriginal and Torres Strait Islander peoples.
Taking inspiration from the US Civil Rights Freedom Rides, a group of 30 University of Sydney students, the Student Action for Aborigines (SAFA) group, hired a bus and set off on a 15-day journey through regional NSW.
Led by civil rights activist Charles Perkins –who went on to become the first Aboriginal man to graduate from an Australian
University – the Freedom Ride aimed to bring attention to the poor living conditions and discrimination faced by Aboriginal people.
The group travelled through regional NSW, starting in Wellington, Gulargambone and Walgett, and then moving through Moree, Boggabilla, Tenterfield, Grafton, Lismore, Bowraville and Kempsey, exposing racial injustice and building momentum for reconciliation action in Australia.
All personal stories, memories, and documents relating to the Freedom Ride are welcome, and with permission, may be shared to ensure the legacy is widely known.
The Freedom Ride Blue Plaque Trail will capture the stories and events that took place at the key stops on the Freedom Ride journey
and join with the existing Freedom Ride blue plaques at the Wayside Chapel (Potts Point) and Walgett Freedom Ride Park.
Heritage NSW Director Renae Patterson said, “This is a unique opportunity for the people of NSW to have their say and directly contribute to helping us determine where the plaques will be located and how this important piece of our history is commemorated.
“We want to hear from those who were there, those who remember the events, and those who have personal connections to the towns, people and locations on the route.
“We encourage everyone to share their stories; your input will be vital in shaping this memorial and bringing the history of the Freedom Ride to life for generations to come.”
Earlier this year, the State Government marked the 60th anniversary of the 1965 Freedom Ride with funding to complete
a community pavilion in Walgett, along with unveiling a blue plaque in the town to commemorate the historic event.
To contribute your story or suggest a location, fill out the submission form at https://www.haveyoursay.
nsw.gov.au/freedom-ridetrail-blue-plaques-nsw
The submission form will be open until Sunday 30 November.
Heritage NSW will also be consulting with stakeholders, including relevant First Nations groups, and visiting towns along the trail to hear directly from communities. Blue plaques are located throughout NSW, recognising the events, groups and people who contributed to the rich history of the state.
q Student Action for Aborigines members standing alongside the bus in February 1965. Photo: Mitchell Library, State Library of New South Wales and SEARCH Foundation.

Australian bat lyssavirus
By Sis HIGGINS
AS bat season arrives on the North Coast, health authorities are warning residents to take extra care and avoid all contact with flying foxes or microbats.
A spike in sick and distressed bats arriving at wildlife hospitals across Northern NSW and Southern Queensland in recent weeks has prompted the alert.
Authorities stress that touching or handling any bat, no matter how injured or unresponsive it may appear, puts people at risk of infection and viruses, including the deadly Australian bat lyssavirus.
Regional Director North Coast Population and Public Health Dr Valerie Delpech, urged the community to stay
clear of bats.
“Although it may be difficult to ignore the plight of an injured, distressed or sick animal, we urge residents not to touch or attempt to cover any bat they might come across, rather, call your nearest wildlife rescue service to come to its aid,” Dr Delpech said.
“If you see a dead flying fox in a public area, contact your local council and ask them to dispose of it.
“Anyone who is bitten or scratched by a flying fox or microbat should immediately wash the wound thoroughly with soap and water for at least 15 minutes, and apply an antiseptic with anti-virus
action (such as those outlined in the NSW lyssavirus factsheet) after washing.
“[They] should also seek medical attention as soon as possible to assess whether they are at risk of infection and to access post-exposure treatment and vaccination if required.
“Getting post exposure treatment as soon as possible is crucial as there is no effective treatment once the symptoms of Australian bat lyssavirus commence.
“It is almost always fatal.”
Dr Delpech said the warning comes at a critical time, with warmer months bringing increased bat activity.
By Sis HIGGINS
OCTOBER is Mental Health Month; a timely reminder that Mid North Coast residents can access free support programs through Healthy Hub Connect.
The service, funded by the Healthy North Coast Primary Health Network,
provides a range of free, accessible support options from Kew to Tweed Heads.
Permanent hubs operate in Port Macquarie and Coffs Harbour with outreach locations bringing care closer to smaller communities.
Aimee White, Manager of Engagement and
Experience for Adult Mental Health Services, said people can reach out however they feel most comfortable.
It can be by phone, email or by referral through their GP.
“Our friendly team understands that asking for help can feel daunting, which is why we’ve created
a ‘no wrong door’ approach.
“The important thing is finding what feels right for you and your unique circumstances.
“Everyone’s journey is different.
“What works for one person might not work for another, and that’s completely okay.
Services available include:
- Men’s Wellbeing Matters, suicide prevention support
- Low Intensity Mental Health Service, for those needing gentle support
- Youth Severe and Complex Mental Health Service (YES), specialised
youth care
- Choice of Mind, clinical care coordination
- Healthy Minds
Psychological Therapies, counselling services
To connect with support, call the Medicare Mental Health phone line on 1800 595 212 or ask your GP for a referral.
By Andrea FERRARI
SURF Life Saving North Coast (SLSNC) observed the official beginning of the patrolled beach season with the Raising of the Flags at Woolgoolga Surf Life Saving Club on Saturday 27 September.
It also signalled the start of the Nippers season.
SLSNC continues to be supported by Newcastle Permanent through an ongoing partnership of almost 20 years.
Newcastle Permanent Coffs Coast Mobile Home Lending Specialist Grant Douglass joined Surf Life Saving North Coast Branch
President Les Pepper and members of Woolgoolga Surf Life Saving Club for the ceremony.
Last season, Newcastle Permanent supported almost 900 Nippers across eight clubs in the region from Nambucca Heads to Minnie Water-Wooli to learn essential skills including surf awareness, CPR and
Best on ground
STORY STARTS on BACK COVER, Page 36
and a goal in his side's 31-point win.
The premiership victory capped off a breakout season for the young midfielder, after being named in the SANFL Team of the Year.
Anderson averaged 20.1 disposals, 5.3 marks, 3.8 clearances, and 4.6 tackles a game for the season.
The premiership winner has spent the last three years plying his trade in South Australia, playing in a league that is regarded as one of the top four in the country.
rescue techniques while also giving participants the chance to enjoy fun, beachbased activities.
"The raising of the flags and Nippers season launch are significant dates on our calendar that signal more than just the start of the warmer weather but are a reminder of the dedication and hard work of our Surf Life Savers that serve the community," Mr Douglass said.
"We're honoured to have partnered with Surf


Life Saving North Coast to ensure the sustainability of this service and the Nippers program, as well as the recruitment, training, recognition and retention of local life savers.”
Mr Pepper highlighted the importance of vigilance and community spirit this season, given how busy last summer was for volunteers.
"Over the course of the summer, our volunteers took nearly 820 preventative measures, clocking up over 19,000
patrol hours, which is no small feat," he said.
“[There were] 90 first aid cases, 70 emergency response incidents and more than 20 lives saved at our beaches.
“Nippers is a fantastic stepping stone for young people to start their journey towards becoming skilled lifesavers, who are essential to help ensure safety.
"We're excited to be back for another season and are extremely appreciative of Newcastle Permanent’s
continued support, which allows us to have the appropriate resources and tools to keep our beaches welcoming and safe for all."
Newcastle Permanent invests almost $1.5 million into local communities each year through its partnerships, employee donations, volunteering and fundraising programs.
For those interested in joining the Surf Life Saving community, more information can be found at slsnorthcoast.com.au.
KORORA sports star Valla Parsons is fast making a name for herself on the footy field.
The 12-year-old is excelling at Australian Rules Football, and recently represented her State at the national schools championships.
Valla was a member of the NSW Sapphires who were runners-up at the School Sport Australia – Australian Football Girls 12 years titles
at Maroochydore.
Member for Coffs Harbour Gurmesh Singh on Tuesday presented Valla with a NSW Government State Representative Award in recognition of her achievement.
“It’s important we celebrate our successes and Valla certainly has plenty to cheer about at the moment,” Mr Singh said.
“She is a fantastic
ambassador for the Coffs Coast and she has worked hard to gain representative honours.
“Valla’s dedication will take her a long way in her chosen sport. She is assured of a bright future.”
Valla is a year six Kororo Public School student and plays for the Northern Beaches Blues in the AFL North Coast’s Youth Girls 13s competition.

q Coffs Harbour tennis 1975 Doubles Champions Mike Cain, then 27, and Peter Leonard, 29.
By Andrea FERRARI
MIKE Cain and Peter Leonard have reunited to celebrate the 50th anniversary of winning the Coffs Harbour Tennis Open Men’s Doubles.
Meeting earlier this month, the men reminisced about their success in the Coffs Harbour and District Championships at Coffs
Harbour Town Tennis Courts.
Mike Cain and his family moved to Melbourne three years later and the men never got to defend their title.
Mike, 77, and Peter, 79, reunited in Coffs over morning tea and reflected on their shared tennis history.
They recall their actionpacked match being played on a clay surface court with
the first set going to their younger opponents, 6-4.
This upset the pair as it was the first set of tennis they had lost that season.
Peter told News Of The Area he remembers being very nervous, as it was his first Open Tennis Final.
He was renowned for his powerful forehand shots, but they were missing the

sideline that day, until Mike settled him down.
From the second set, Peter pulled out the forehands.
Mike’s net play followed and they took the second and third sets 6-2, 6-2, which meant the title was theirs.
Peter comes from a tennis family from Johns River and played from the age of five.
The pupils of Johns River played tennis before school and during the lunch break.
“Our teacher Ron
Delvesas played with us and would not allow his pupils to defeat him,” he said.
“So, if he and his partner were down five games to the opposition, he would blow the whistle and tell us it was time to return to class.”
Peter still plays social men’s tennis on Saturday mornings, at the tennis complex where he and Mike won their doubles.
“We both still have our trophies.”
In 2001, Mike travelled
from Melbourne to compete in the Coffs Harbour Men’s Tennis Competition Reunion. He continued to play until 10 years ago when leg injuries forced him to retire.
“We often mention our tennis victory and remind one another that we remain undefeated in this event… how vain of us,” he said of his friendship with Peter.
“My mother, who was a better player than I, always said friends from sports are genuine.”

By Andrea FERRARI
WOOLGOOLGA Rebels
Cricket Club has welcomed international cricketer Mussa Chaudhry from England’s Eckington Cricket Club in Derbyshire for the 2025/26 season.
Chaudhry, renowned in England’s club cricket for his strong batting skills, technical ability, and unwavering commitment to cricket, brings talent and enthusiasm to the club.
His move to Australia provides him with the chance to test his skills
in local conditions while sharing his knowledge with Woolgoolga players across all grades.
His signing marks a milestone for the club, providing local players with the opportunity to train and play alongside a proven international cricketer.
“Having Mussa with us is not only exciting for our senior squads, but also for our younger players who will benefit from his skills and knowledge,” said Club Coach and Committee Member Lindsay Mamone.
In addition to
strengthening the senior playing group, the Rebels are also investing in the future of cricket with the launch of a new Under10s Wednesday afternoon competition.
The program begins 15 October, running for eight weeks at Centennial Oval, and is open to boys and girls aged 6–10.
“Using soft Cricket Blast equipment, the competition provides a fun, safe, and social way for children to learn and fall in love with cricket,” Mr Mamone said.
The Woolgoolga Rebels
Cricket Club prides itself on being more than just a cricket club.
“It’s a familyfriendly community with opportunities for first-time players, juniors, and seniors alike”.
New players and families are warmly encouraged to get involved this season.
To register or learn more, visit the Woolgoolga Rebels Cricket Club Facebook page.

AUSTRALIA’s premier youth Touch Football event, the 2025 DoorDash National Youth Championships (NYC) returns this week in Coffs Harbourmarking its second consecutive appearance on the Mid North Coast.
More than 6,000 athletes, officials, and spectators will converge on C.ex Coffs International Stadium for four days of competition, with 125 teams from across the country contesting eight Boys' and Girls' divisions from under-12s through to under-18s.
All Australian states and
Park Beach Mens Bowling Club
By Todd BROWN
OPEN Triples Tuesday 23 September 2025
K Raymond, M Cutts, J Murtas
d D Walker, N Barker, J Barker 23 - 10
C Venturi, L Clancy, C Jones d K Bienefelt, AM Taylor, G Brewis
35 - 12
D Wood, M Prood, P Anderson
Park Beach Women's Bowls Club
By Anne ORR
SOCIAL Bowls Wednesday 24.9.25. V Maher, S Betts, J Pearce-Kennedy
Sawtell Bowls Results
By Geoff HAMPSON
MONDAY Afternoon Bowls
22/9/25
R Redman, S Fleming. G Hampson DEF L Jacobsen, K Taylor, A Day
J Chapman, L Read, N Elford DEF J Fleming, B Connors, B Tremayne
R Hampson, L Mitchell DEF K Mason, R Avery N Luck, L Kratz, D Anderson DEF E Korchma, P Day, J Cherne TUESDAY Ladies Social Bowls
Sawtell RSL Snooker Club
By Ken MASON
TUESDAY 23rd September
2025
Main Draw Winners: - Dave Lewis - R/U - Dave Laneyrie
Consolation Winners: - John Browning - R/U - Mark Styles
Sawtell Golf Results
By Janet O’DOWD
23/9 MEDLEY Stableford A: Phil Elliott 42, Ben Rodrigues 41. B: Anthony Sozou 41, Dave Lovett
38c/b. C: John de Rouffignac 41c/b, Ken Hoy 41. Balls to 36. Eagle on 4 Allan Robertson. NTP 7 A: Todd Riley, B: Ian Reynolds (pro pin), C: Mark Salter. NTP 11 A: John Veness, B: Greg White, C: Mark Wallis 24/9 American Foursomes
Margaret Gill & Annie Waters
68.875, Pam O'Sullivan & Carole
territories will be represented by 21 competing entities, with the Brisbane Cobras and the South Queensland Sharks entering the largest contingents at fourteen teams each.
“The NYC is one of two flagship national events on the Touch Football calendar, playing a vital role in both mass participation and elite talent identification - while also delivering an economic impact of more than $5 million for New South Wales and the Coffs Harbour economy, as Touch Football Australia (TFA) continues its long-standing
d N McVicar, P Rambow, M Finn 18 - 16
S Clouten, G Power, S Crawford d D Powell, R Jupp, M Berube 18 - 17
D Catling, T Wisley, M Monck d J Long, R Aitken, B Johns 22 - 16
G Williams, R Beaumont, A Campbell d D Francis, P Wroe, S Bailey 25 - 9
A Stone, P Lilly, A Worboys d T Brown, J Clarke, S Jones 25 - 20
M Miller, G Stanford, G Hinsley d S Kindred, P Lawrence, K Kaaden
def E Blanton, K Wilson, M Long 4214; J Clarke, Y Hinsley, J Slater def P Poulton, R Jupp, R Crestani 27-10; A M Taylor, R DeMeio, L Loadsman, def C Keogh, D Hargraves, Y Schmidt 25-17; V Valentine, K Blow, C Sheridan def C McVicar, L McLeod, A
23/9/25
L Savage, L Mitchell DEF N Elford, N Feltrin
H Muir, J Fleming, J Poletti DEF C Veerhuis, B Connors, D Grebert
K Weir, J Cox, M Sharman DEF
M Friend, A Bailey, L North
A Day, G Staunton-Latimer E Tindall DEF A Day, M McDonald, M Baguley
H Dodd, C Irvine, J Townsend
DEF L Kratz, C Dodds, K Lewis
WEDNESDAY Men’s Social Bowls 24/9/25 N Stahlhut, N Wong, P Roach DEF J Chapman, D Isaacs, A Robertson
Sawtell Veterans Golf
By Ian REYNOLDS
RESULTS for 29th September 2025
9 Hole Stroke Net 20 Starters
Ladies
Lynda Wood 31, Rossi Hrncir 32
Men Steve Thompson 32 w/c/b, Jack Odendaal 32, Andy Carroll 33
Davis 69.5, Pauline Barnes & Rebecca Goldsmith 71.125, Robyn O'Dwyer & Karen Wilson 72. Balls to 74.375. NTP 7 3: Narelle Hall, pro pin Wendy Mason. NTP 11 1: Rebecca Goldsmith, 2: Kerry Humphreys
25/9 Play 9 Kelvin Wilton 20, Neil Belling 19c/b. Balls to 19c/b
26/9 Medley Stableford Kerrie Pitman 43
27/9 Stableford A: Cameron Arnold 38c/b, John Veness 38c/b. B: Brett Long 43, Bruce Lynch 42c/b. C: Mark Wallis 43, Bob Everitt 42. Balls to 35c/b. Eagles on 4 Asttan
q More than 6,000 athletes, officials, and spectators will converge on C.ex Coffs International Stadium for four days of competition.

partnership with the region,” TFA said in a statement.
The 2025 DoorDash National Youth Championships will be
24 - 17
W Moore, R Douglas, L Morris d J McLeod, C Keogh, D Hull 19 - 14 Stan, J Swan, D Condon d Macca, D Wilson, B Nicko 18 - 16
C Weatherall, D Valentine, V Valentine d D Richard, G Richard, R Alford 24 - 18
Triples Thursday 25 September 2025
D Catling, B Garner, B Trotman d P Woodsell, S Bailey, L Morris 24 - 15
D Powell, G Brewis, G Stanford
Worboys 30-18; F Gaunt, P Garner, S Hancock def D Doyle, S Wilson, L Clancy 25-23; M England, M Watt, J Woodford def C Treharne, J Farrell, D Futcher 34-11; C Domjahn, J Kennedy, M Monck def B Bodel, A Orr, E Kidd 34-10. Friday 25.9.24.
P Collins, R Williams, B Martin DEF R McLennan R Wardrop, S Wilkinson
P Covington, W Vaughn, J Townsend DEF C Christian, D Wheeler, E Nicolaou
N Kotrozos, J Oates, S Sillar DEF W Hall, D Anderson, A Berry
A Lavelle, D Melia, B Blight DEF K Sharman, L Zecchinati, A Wagstaff
N McClelland, J Richardson, J Urge DEF I Maderic, G Walsh, M Jenkins
M Aujard, G Campbell, B Newling DEF B Fitzpatrick A Jones, A Taylor
Urunga Men's Veterans Golf
By Ross HARDAKER
SEPTEMBER 29th
Single Stableford 26 players contested today's event, with the winner being Peter Wood, with 38 points, runner up with 37,
Hope & Clint Samuels. NTP 7 A: James Murdoch, B: Bruce Lynch, C: Rodney Hope. NTP 11 A: Clint Samuels, B: Stephen Dawson (pro pin), C: Tony McKenna
Ladies Stableford Gayle James 40. Ball to 37c/b Freeforall 4 Ball Brenda Connors & Lyn Lightfoot 32. Individual Elaine Everitt 27, Adele Woodward 24. NTP Brenda Connors. Saturday Sal Jean Dummer. Saturday Sam Linda Rankin
28/9 Medley Stableford Scott Pollard 40, Lynne Rapley 39. Balls to 33c/b
held at C.ex Coffs International Stadium from Wednesday 1 to Saturday 4 October 2025. Fans can watch the event
live and free on Kayo Sports in Australia, Sky Sport in New Zealand, and Sky Sport Next in other global territories.
d S McCunden, P Wirth, T Cooper 18 - 17
N Bowes, R Douglas d B Edwards, C Lloyd 27 - 14
P Lilly, K Johnson, M McCabe d L Goodacre, M Finn, R Harris 25 - 6
G McAenery, C Davis, S Dodd
d C Brian, K Morrison, G Hinsley 20 - 12
J E, Hans, Grim d M Miller, W Moore, S Jones 23 - 16
S Ward, J Thorn, D Condon d P
R Aitken, B Johns def C McVicar, N McVicar 21-10; Y Schmidt, D Hargraves def B Edwards, F Gaunt 11-10; L McLeod, J Slater def D Futcher, D Lindner 21-12; T Aarts, S Clouten def M Cutts, J Murtas 16-11; S Crawford, D Francis def C
A Baker, A Sorbello, D Hyde
DEF R Smithers, S Shaw, R Peterson
J Hall, T Mitchell, L Preston DEF T Brooks, R Cridge, G Denniss
G Fisher, D Frost, N Sillar DEF I Muller, P Cook, A Birse
FRIDAY Mixed Social Bowls 26/9/25
J Hall, N Staff, E Tindall DEF N Kotrozos, J Oates, J Townsend
A Lavelle, A Baker, B Blight DEF P Webster, M Gibbons, M Clarke
J Chapman, M Baguley, A Sorbello DEF J Urge, N Nicolaou, T Karam
J Fleming, J Wills, W Meadows DEF N Elford, A Day, Jan Townsend
Garry Matthews, and 3rd Bob Jones 36 c/b. Run-down Ross Williams, Bruce Parker 36,Wozz Rawlings, Andrew O'Keeffe, Paul Bastick 35, Brett Bosbach, Tom Faulkner 34. Bradmans Arthur Hassett 20. NTPs 3rd Paul Bastick,
Woopi Monday Vets Golf
By Shirley STRAUCH
MONDAY 22nd. Sept 20 starters
Winner Col Cafferky 29
R/U Chris Robinson 31
2nd. R/U Di Richards NTP 11th. Mark Ashcroft Di Richards NTP 12th. Chris Robbo NTP 15th. Col Wade Robin Skinner
Putting Paul Mcrea 15
Roger Castley took out the NAGA
North, C Hansen, J Swan 26 - 12
S Kindred, J Kindred, G Kindred d J Lowndes, A Baker, M Berube 19 - 14
N Dean, P Rambow, J Bishop d C Weatherall, D Valentine, T Erskine 26 - 24
S Macca, R Aitken, J Long d R Wisley, K Kaaden, P Evans 28 - 17
G Williams, R Beaumont, A Campbell d C McLeod, P Newman, D Hull 15 - 11
Venturi, L Clancy 20-16; J Farrell, A Stone def P Poulten, S Bailey 20-19; D Doyle, C Sheridan def J Alford, L North 19-13; K Blow, T Blow def M England, C England 23-16; L Loadsman, R DeMeio def S Hancock, R Jupp 16-13.
J Flynn, G Flynn, D Hyde DEF G Latimer-Staunton, G Peel, B Fitzpatrick
T Brooks, R Cridge, A Taylor DEF P Day, B Hamilton, S Wright K Sharman, C Christian, A Berry DEF N Wong, K Lewis, C Dodds
N Luck, R Avery DEF L Jacobson, S Fleming
P Covington, D Frost, N Sillar DEF W Vaughn, A Wagstaff, D Anderson H Muir, M Friend L Mitchell DEF K Taylor, G Hampson, P Roach J Brown, J Smithers, R Morris DEF K Lowry, K Stirling, W Bujeya
9th Gary Teale, 18th Kim Michelsen.
Longest Putt Wozz Rawlings.
Slab Winner Gary Teale, again!
Bruce Parker again shot under his age, with 85 off the stick. Bruce will turn 90 in a couple of weeks. We'll done young fella.
with a 46, as for the Frog, it seems to be MIA. Hopefully it will be recovered.
There were 2 birdies, Dick Cooper on the 10th. & Col Wade on the 15th.
Unrealestate Agent
URUNGA/BELLINGEN
IGA Supermarket
Spar Supermarket Urunga
Foodworks Urunga
Urunga Bowling Club
Welcome Dental Urunga
Lindsay’s Oysters Kombu Wholefoods
Fermount Fire Station
Bellingen
Cardows Urunga
Cex Woolgoolga Lawn Bowls
By Sue BRACHER
TUESDAY 23/9/25 (social pairs)
Rink 2: J C, S Dodd(D) M Lambert, C Latham. Rink 3: L Walsh, Freddy C, R Bennell
( D) C O’Dwyer, G Lane, P Diamond. Rink 4: L Walsh, G
Coffs CEX Social Golf
By Steve ROBINSON
28 SEPTEMBER 2025
Coffs CEX Social Golf Club
Coffs Harbour District Darts
By
Ray BEASLEY
SAWTELL RSL Club
Winter Comp
Monday 22 September
Thunderstruck def Fluke Shots 5-4
Bull Finish def Surgical Steel 7-2
Coffs Harbour Golf Club
By Vicki SILVER
52 MEMBERS and visitors played a Stabrose Fours Stableford 9 hole event in beautiful sunny conditions
Coffs Harbour Ladies Golf Results
By Leah RAY
TUESDAY 23rd SEPTEMBER
9 HOLE SINGLE STABLEFORD
A GRADE WINNERS 1. Janette Curran 24, 2. Phillipa Burrows
Coffs Harbour Rifle Club
By Geoffrey HART
September 24- Howard Street
Rimfire Range. The 90m Field Class match was conducted with 22 participants. Master Grade: Jake Buckley 94.5, Daniel Finlay 92.7, A Grade: Stuart D 99.10, Phillip Payne 85.2, Geoff Slattery 80.2, Cherelle Steinhardt 79.3, Johan Greyling 76.4 B Grade: Andrew Graham-Higgs 85.3, Sam Matten 84.2, Philip Grace 52.0, C Grade: Pete C 74.1, Sam Atkinson 69.4,
Coffs Table Tennis Results
By Margaret ILES
FRIDAY 26th September, 2025
Division 1
Lachlan Dierkx d Tim Garrad
3/0, Troy Prystasz d Bo Zhang 3/2, Reece Baker d Tim Garrad
Mid North Coast Veteran Golfers Association
By Colin CUTT
TUESDAY, 23rd September, 2025, 29
MNC Veteran Golfers competed in a single stableford at Sawtell Golf Course. The green
McInerney (D) W Rice, S Rice.
Rink 5: C Nightingale, K Costelloe (D) W Prosser, C Davis. Rink 6: T McKenzie, P Buck (D) A Plain, B Merchant. Rink 11: M Hopes, J Wilcox (D) S Oliver, R Shaw. Rink 12: A Wroe, R Gurber (D) H Schultz, J Taylor. Wednesday 24/9/2025. (Wanderers) Rink 3: G Burgess, S Oliver, I Brien (D) M Lambert,
played on Sunday 28 September 2025 at South West Rocks, Single Stableford.
Results were as follows:
Winner: Mitchell Howe (35pts).
Runner Up: Catherine Robinson
Warriors def DILLIGAF 5-4
Bad Habbits def Who Darted 8-1
100s
Elaine (1)
Asttan (2)
Ben (1)
Christian (2)
Craig S (2)
Dave H (4)
Garry (2)
Kevin (1)
winners as follows:
First with a score of 31 points
Vicki Silver
Garry Silver
Geoff Clerke
Jim McIntosh
Second with a score of 29
Meryl Fisher
Carlene Bath
22 (CB) B GRADE WINNERS
1. Lyn Whitelaw 19, 2. Jenny Carson 18 NTPs - 12th hole - Denise Turnbull, Barbara Wilson, 15th - Jenny Malouf
WEDNESDAY 24th SEPTEMBER
SINGLE STABLEFORD A GRADE
WINNERS 1. Lynda Butler 40, 2. Gloria Hickey 39 (CB) 3. Ada
Mitch Upton 68.2, Russell Williams 63.1, Billijean Atkinson 61.0, Claude Besse 56.0, Member-926 55.0, Aaron Drayton 54.2, Matt Miller 42.0, Danielle M 39.0, Craig M 32.0 - Using a rest, Thomas James 85.1
The 50m F-Class match was conducted with 19 participants. Cherelle Steinhardt 197.16, Daniel Finlay 197.13, Johan Greyling 197.10 Pete C 192.5, Michael Walker 192.4, Billijean Atkinson 191.6, Thomas James 190.8, Member-677 188.8, Russell Williams 188.4, Mitch Upton 184.1,
3/0, Lachlan Dierkx d Bo Zhang
3/0, Reece Baker d Bo Zhang 3/0, Lachlan Dierkx d Troy Prystasz
3/0, Reece Baker d Troy Prystasz
3/0, Bo Zhang d Tim Garrad 3/1, Reece Baker d Lachlan Dierkx
3/0, Troy Prystasz d Tim Garrad
3/1. WINNER: Reece Baker from Lachlan Dierkx.
Division 2
renovations made for difficult putting and windy conditions prevailed, but all 18 holes were open and the course has dried out.
Winner – Ian Finn 40, 1st runner-up Rodney Macpherson 36, 2nd runner-up Chris Cuthbertson 35 c/b.
NBTP’s: 3rd - no
B Pendred, P Jones Rink 4: C Nightingale, Freddy C, J Hampstead (D) G Lane, J Simmons. K Costelloe. Rink 5 Bear, R Pillon, D Mason (D) J Whalen, T Collins, J Taylor. Rink 6: J Martin, P Diamond, I Gentle (D) P Hatton, S Ferro, L Boom.
Friday 26/9/2025: (3bowl pairs) Rink 2: L Walsh, A Plain (D) J Lynn, C Davis. Rink 3: (34pts).
Ball Winners: Scott Croft (33), Rick Paxton (31), Jose Caravante (31), Maurice Tate (30), Izzy Caravante (30), Amrik Thandi (30).
NTP’s: Scott Croft (4th), Troy
Kurt (1)
Micheal (2)
Paul (2)
Peter (2)
Reg (3)
Ricky (3)
Rob Ho (1)
Sam (1)
Steve (1)
Trevor (2) Will (3) High pegs
Mark Cooney
Roger Martin Third with 28 points
Stuart Malouf
Jenny Malouf
Robert Standing Grazi Toscan Fourth 27 c/b
Lynch 39 B GRADE WINNERS 1. Kit Goodsell 40, 2. Di Ratcliffe 38, 3. Dallas Hogan 37 (CB) C GRADE WINNERS 1. Lorraine Garlin 40, 2. Joanne Hickey 39, 3. Rose-Marie Sercombe 37 (CB) NTPs - 3rd hole - Ada Lynch, Maria Sanford, Carlene Bath, 22nd - Lindy Ingham,
Philip Grace 181.4, Sam Atkinson 181.2, Member-926 176.1, Sam Matten 175.0, Claude Besse 173.2, Saxon G 173.0, Craig M 166.0, Danielle M 163.0, Andrew GrahamHiggs 140.2
September 27, 500m Long Range event. F-Open (from a possible 120): Greg Roberts 120.12, Theo G 120.11, Mykel Watson 119.9, Armand F 117.12, Bruce Hartmann 117.6, Joel Walker 115.6, Anthony Khalil 111.7. F-Standard (from a possible 120): Al Phillips 116.11, Robert Ramsey 109.3, Cherelle Steinhardt 103.2,
Lulu Zhang d Patrick Howard 3/0, Char Berglund d Nick Jankovic 3/2, Nicole Goh d Sharee Templeton 3/1, Lulu Zhang d Sharee Templeton 3/0, Nick Jankovic d Nicole Goh 3/1, Char Berglund d Patrick Howard 3/1, Lulu Zhang d Char Berglund 3/0, Nick Jankovic d Sharee Templeton 3/2, Patrick Howard d
one on green, 7th - Neil Thomas, 11th - Dave Salvin, 15th -Neil Thomas.
Ball run to 32 pts.
Also, on Tuesday, 23/09/2025, 17 golfers competed in a single stableford at Safety Beach Golf Course in good golfing conditions. Winner – Eric Slater 38, 1st runner-up Maurie
John, B Parker (D) N Haines, J Hampstead. Rink 4: J Taylor, P Buck (D) J Burgess, K Costelloe. Rink 5: H Pallister, D Mason (D) W Rice, S Rice. Rink 6: I Coltman, B Symes (D): J Corkett, A Corkett. Rink 11: G Martin, S Oliver (D) D Chandler, Freddy C. Rink 12: D Foster, L Walsh (D) H Katala, G Pallister. Rink 13: H Schultz, R Bennell (D) G Lane, R Shaw.
Henderson (16th), Izzy Caravante (2nd Shot 17th).
Chip In’s: Scott Croft
Next Game is at Sawtell on Sunday 12 October 2025, 7.00 am Tee Time. All Welcome.
Craig S (57)
Ray (58)
Will (70)
Leader Board
Bad Habbits 68
DILLIGAF 66
Bull Finish 62
Warriors 58
Fluke Shots 58
Surgical Steel 45
Thunderstruck 43
Who Darted 26
Jean O’Connor
Jackie Wilgress
Anne King-Scott
Betty Snow
Fifth 27
Alan Garlin
Barbara Wilson
Julie Reynolds
Rod Bradsgrove
Emma Mayfield-Smith, 26thTrish Jackson, Karen Webster, Vicki Kelly SATURDAY 27th
SEPTEMBER OVERALL WINNERS
1. Maureen Cotsell 40, 2. Kerryn Little 37 (CB) 3. Kerry Farmer 37 NTPs - 3rd hole - Karen Brown, 6th - Kerry Wilson, 12th - Norma Andrews, 15th - Ada Lynch
Tony Queitzsch 99.1, Cassandra Fullager 90.2. Sporter(from a possible 100): Lockie Knight 98.9, Dave K 97.10, David Hartmann 95.5, Wendi Holl 91.4
The Bisley Match. F-Open (from a possible 60): Mykel Watson 60.7, Joel Walker 59.5, Greg Roberts 59.4, Theo G 58.5, Bruce Hartmann 58.5, Anthony Khalil 57.3, Armand F 57.3. F-Standard (from a possible 60): Al Phillips 58.2. Sporter (from a possible 50): Lockie Knight 49.5, Cherelle Steinhardt 48.4, David Hartmann 44.1
Nicole Goh 3/1, Lulu Zhang d Nicole Goh 3/2, Nick Jankovic d Patrick Howard 3/1, Sharee Templeton d Char Berglund 3/1, Lulu Zhang d Nick Jankovic 3/0, Char Berglund d Nicole Goh 3/2, Sharee Templeton d Patrick Howard 3/2. WINNER: Lulu Zhang from Nick Jankovic.
Tate 37.
NTP’s: 11th (Proplay) Phil Hemming – Thanks to Terry Perfrement for his sponsorship.
4th - no-one on green, 7th - David Nicholls, 9th - Phil Hemming.
Ball run to 32 pts.
Jack Dean
20/05/1914 - 06/10/1988

LYLA WINKLER 05/02/1944 - 02/10/2019
6 Years have now


27th September 2025
Passed away at the Coffs Harbour Health Campus. Husband and father. A special thank you to Dr Colin Leal, Dr Tawadrous, Dr Razak and all the staff at the Coffs Harbour Health Campus.
Aged 79 years

30.11.1935 - 24.09.2025
Peacefully passed at The Shoreline Aged Care Facility Coffs Harbour, with loving family by her side. Late of Coffs Harbour, formerly of the Clarence Valley. Loving wife of Bryan (dec’d).
Much loved partner of Frank. Adored mother and mother-in-law of Scott & Sandy, Kylie & Sam and Veronique & Peter. Devoted nanny and great-grandmother of Nadine & Sam, Mitchell & Brook, Theo, Delilah, Mehau, Cass, Ruby & Heath and Lockie.
Aged 89 Years
Marlene’s Funeral Service was held in the Chapel of Hogbin Drive Crematorium & Memorial Gardens, Stadium Drive, Coffs Harbour on Wednesday 1st October 2025.
KEITH LOGUE & SONS
FUNERAL DIRECTORS Coffs Harbour
6652 1999

As per Steve’s wishes, a private cremation has been held.
(02) 6651 5007
www.funeralcoffsharbour.com.au



18th August 1930
27th September 2025
Dearly loved wife of Vic (dec). Cherished mother and mother-in-law to Rhonda & Stephen Cooper, Allan & Sue, Carolyn & Geoff Pearce. Nan to Michelle, Kelly, Damien, Peter, Kirralee, Wayne, Chris and their partners. Great-Nan to 12 and Great-Great-Nan to 1. Special friend to many, back in Vic’s arms.
Aged 95 Years
Tears in our eyes will wipe away but the love in our hearts is here to stay. Lyn’s service was held on Thursday, 2nd October 2025 and respecting her wishes she was cremated. A recording of the service is available.
VICTOR RULLIS
FUNERAL SERVICES
(02) 6651 5007
www.funeralcoffsharbour.com.au


HARDIE, Jean Marie
25th September 2025, peacefully at Mater Christi Aged Care Facility
Toormina, formerly of Sawtell. Dearly beloved wife of Barry (dec’d). Loving mother and mother-in-law of Wesley & Debbie, Owen & Jeab, Donna, Dean and Rohan & Lyn. Adored grandmother and great-grandmother of their children.
Aged 90 Years
Reunited With Barry
Relatives and friends are kindly invited to attend Jean’s Funeral Prayers to be celebrated in the Chapel of Hogbin Drive Crematorium & Memorial Gardens, Stadium Drive, Coffs Harbour on Friday 3rd October 2025 commencing at 1.00 pm.
Please find livestream details on Keith Logue & Sons website.
KEITH LOGUE & SONS
FUNERAL DIRECTORS
Coffs Harbour
6652 1999


Donald Arthur Langley
28th September 2025
Passed peacefully with family at Coffs Harbour Grange Care Community.
Much loved husband of the late Isabel Langley. At rest with his Lord. A loving father and father-in-law to Peter, Graeme and Kerry, Raffaela & David. Grandfather to Brendan, Timothy, Nicholas, Damian, Ethan and Alana. Great Grandfather to Flynn, Harrison, Summer, Elodie and Violet. He is sadly missed by his friends and family.
Aged 92 Years
Forever in our hearts and forever loved. Relatives and friends are warmly invited to attend Don’s farewell and celebration service to be held on Friday, 10th October 2025 at 10.30am in the Chapel of the Coffs Harbour Crematorium, Coramba Road, Karangi. Livestreaming of Don’s service is available.
VICTOR RULLIS
FUNERAL SERVICES
(02) 6651 5007
www.funeralcoffsharbour.com.au





Memorial Notice

25th September 2025, peacefully at Coffs Harbour Health Campus.
Late of Nana Glen. Dearly beloved husband of Barbara. Loving father and father-in-law of Trevor & Julie, Ross & Liz, and Leon. Grandfather of Katie, Emma, Rachel, Lauren and great-grandfather of their children.
Aged 91 Years
Relatives and friends are kindly invited to attend Noel’s Funeral Service to be held in the Chapel of Hogbin Drive Crematorium & Memorial Gardens, Stadium Drive, Coffs Harbour on Friday 3rd October 2025 commencing at 11.30 am.
Please find livestream details on Keith Logue & Sons website.
KEITH LOGUE & SONS
FUNERAL DIRECTORS
Coffs Harbour 6652 1999

Ernest Robert Newcombe ‘Ernie’
29th September 2025
Passed away peacefully at Coffs Harbour Health Campus. Late of Toormina. Loving Husband of Sylvia (dec). Loved Dad of Andrew (dec), and Richard.
Aged 100 Years
Reunited With Sylvia & Andrew
Family and friends are warmly invited to attend Ernie’s funeral service to be held on Tuesday, 7th October 2025 at 10.30am in the Chapel of the Coffs Harbour Crematorium, Coramba Road, Karangi.
VICTOR RULLIS
(02) 6651






Ian ‘Stretch’
22nd September 2025, peacefully at Bellinger River District Hospital surrounded by close family and friends. Late of Coffs Harbour. Proud and loving father of Dale. Loved son of Keith & Marie (both dec’d) and brother of Ray, Neil and Kairi.
Aged 60 Years
Courageous To The End
Relatives and friends are kindly invited to attend Stretch’s Funeral Service to be held in the Chapel of Hogbin Drive Crematorium & Memorial Gardens, Stadium Drive, Coffs Harbour on Tuesday 7th October 2025 commencing at 1:00 pm.
Please find livestream details on the Hogbin Drive Crematorium Facebook page.
Hogbin Drive Crematorium Stadium Drive, Coffs Harbour Ph: 6652 2822


Barbara Ann
25th September 2025, passed away peacefully at Hillside Aged Care, Figtree. Late of Wollongong, formerly of Coffs Harbour. Dearly beloved wife of Allen (dec’d). Much loved mother and mother-in-law of Peter & Kym, Susan, Ian & Suzanne, Lynette & Leo, Robert & Anna and Janice & Craig. Adored nana and great-nana of their children. Order of Australian Medal recipient for her tireless efforts to the community including generous donations towards the builds of the Coffs Harbour Heated Pool, the Coffs Creek Walk and the Coffs Harbour Conservatorium. Barbara had a true passion for her community including teaching Learn To Swim for free to thousands of children over a twenty year period, she continued her personal passion for swimming up until the age of 89. She had a great love of family, cycling, bushwalking, exploring, golf, tennis, sewing, playing cards, bridge, reading, piano, snow and water skiing and holidays. Barbara will be remembered fondly by all who had the benefit of knowing her.
Aged 93 Years
A Remarkable Lady Who Leaves Behind An Inspirational Legacy Barbara was privately cremated as per her wishes.

Relatives and friends are kindly invited to attend Barbara’s Memorial Service to be held in the Chapel of Hogbin Drive Crematorium & Memorial Gardens, Stadium Drive, Coffs Harbour on Saturday 25th October 2025 commencing at 2.00 pm.
Please find livestream details on Keith Logue & Sons website.
KEITH LOGUE & SONS
FUNERAL DIRECTORS
Coffs Harbour 6652 1999

CLIVIA plants, flowering $4ea. 0429 853 180 f031025
BAMBOO wireless keyboard. Something different. New in box. $35 Photos available 0490 161 119
BED frame, Queen pine legs (5) and particle board sheeting. Pine bookcase bed head Photos available. $90 ono 0415 669
BABY pram, 3 wheels, for two children. Excellent condition $99. 0415 981 605
2 KS single beds + mattresses linen & pillows; 5 seater corner lounge, incl 2 recliners; Brass Q bed frame & base; White iron Q bed frame + mattress; 2 small bedside tables; White tall timber bookcase; 2 yellow bar stools. Bonville 0422 044 420
12V Battery AMP-TECH AT 123500. Very clean only once used. $100. ph 0438 531 887
44 gallon drum with lid. $70. 66538337 / 0419 166 688 F110425
1930s vintage cane komode chair w/ genuine fowlerware porcelain chamber pot $95 Photo can be supplied. 0490 161 119
1976 F100 guards, doors grills and bonnet from $100. 0499 684 401
AIRFRYER 8 litre Russell Hobbs 2 drawers Used once. $80. 0438 531 887
COMMONWEALTH bank original 1988 $5 coin in mint condition to celebrate opening of Parliament House.
$45. 0490 161 119. Photos can be sent.
DINING chairs, grey velvet swivel near new 4 available $40ea ono 0400 513 862 F020525
DOG house, smallmedium $15 6656 4700
DOOR Gym set new
$50. Ph 0412 081 950
DOUBLE bed, white air lift, in box, new. $100 0415 981 605 F300525
E-BIKE, white, as new, selling for medical reasons. Two batteries mid mounted motor price $1,650. 0478 248 667 e261025
ELDERY bed safety rail for seniors brand new in box $65 Photos can be supplied 0490 161 119
FILING Cabinet, steel 3 drawer, w/- ezy glide susp., files, approx. 30. 450 W x 630 x 1.03 H, $40 ono 0415 669 378 F120925
FISHER&PAYKEL top loader washing machine
7kg. See working. $200 0403 857 222
FORD V8 Cleveland and Windsor heads and exhaust manifolds from $75. 0499 684 401 F160525
FOX tail palm seeds $1 each, beautiful North QLD palm 66538337 / 0419 166 688
FRIDGE, Hisense
400L, GC, $150 ono 0439 403 103 e101025
FURRY hood jacket
Ladies size 10, toggle front $25 0407 654 879
GIRLS Dressing Table
Circa 1950’s original mirror & handles $80 0427 544 008
GOLD frame mirror. 75 x 50cm GC $45. Photos can be supplied 0490 161 119
newsofthearea. com.au
HEALTHCARE heavy duty shower stool 250kg with arms. $85. 0490 161 119. Photos can be sent.
HEAVY duty glass table top. 90cm Diameter x 1cm thick $65 Photos can be supplied 0490 161 119
HERO 4 wheel walker w/ seat. 136kg safe working load. $85. Photo can be supplied. 0490 161 119
HOOVER EVC500
Evaporative Cooler, new from Bunnings $299, still in box. $80. 0434212460
HUGE vintage buffet 230cm L x 75cm H x 40cm W, requires minor repairs. $65 0490 161 119. Photos can be sent. F260925
HISENSE 578L sideby-side refrigerator with cold water dispenser. Own tank, no plumbing req. 1790H x 900W x 700D. As new condition $900. 0412 081 950 e031025

KITTY litter house with removal tray. $30 0490 161 119. Photos can be sent.
LADIES clothing mostly new, size 6. Must sell going cheap. Contact Kim 0403 280 231
LAMINATOR, A3. $50 ono. 0466 040 154 F260925
LARGE metal puppy crate. 75cm x 50cm x 60cm H. as new $40 0490 161 119. Photos can be sent.
LEAD light wall unit 390w x 440h x 100d $65 pic avail. 0439 682 267
LEATHER lounge 3 x 1 + 2 x 1, 2 timber outdoor settings & 2 budgies in large cage. 0407 580 436
LOUNGE suite, green fabric, dbl couch + 2 reclining chairs $100 0412 254 563 F310125
LOVELY vertical circular 5 shelves display tower for collectibles etc. $80 6652 3791
MATTRESS, Queen size, 2050 x 1550 x 200 good condition. Best for Rest brand, $100 ono 0415 669 378
MARBLE rolling pin Chill for pastry, crush spices, tenderise meat roll pottery clay $30 0407 654 879
MID century traymobile with bottle holders. $95. 0490 161 119. Photos can be sent.
PAIR of lovely jacquared fabric vintage-style footrest 60cm x 40cmx 30cm H $35 each Photos can be supplied 0490 161 119 F140225
PAPER Shredder, GC Fellows H63. $50 ono 0466 040 154 F260925
PEAK ellipse rollator safewok load 1150kgs only 6mth old As New $95 Photos can be supplied 0490 161 119

Scooter 2024. As new. $6,000ono. 0428 628 105
PLANT tying tape gun + 8 rolls tape + 5,000 staples $100 0407 654 879 PENSIONER
PORCELAIN biscuit jar (8in high) with cream and jam pots, tea strainer and small flat teaspoon holder. $35 0400 641 561
PUPPY grooming table. 90cm x 60cm x 77cm H. Never used. $75 Photo can be supplied. 0490 161 119 F050925
PUPPY crate, large. 75cm x 50cm x 60cm H. Only used for 2 months. $45. Photo can be supplied. 0490 161 119
RAILWAY line small gauge, 70mm high x 5m lengths. Suit cattle grid, $75 each 0499 684 401
RED overcoat size 10
Jigsaw brand fabric made in Italy 80% wool Never used. Pic ava. $95 0439 682 267 F250725
RENAI Gas Heater, GC $100 ono. 0466 040 154
RIGHT hand palm springs golf clubs, 3 4 5 6 7 8 and 9 irons and PW plus 1 3 & 5 drivers. No putter. Suit beginner. $95 0490 161 119. Photos can be sent.
ROLLER blinds to fit window 120cm wide x up to 210cm drop $5each 0400 513 862
SHOES, Birkenstock size 37, narrow fit. Paid $150. selling $50 ono. 0459 040 014 or 6651 4237
SHOES, winter ARA Europe. Black suede Size 37 like new. Worn 3 times. Paid $300, selling $100 ono. 0459 040 014 or 6651 4237 F270625
SINGER sewing machine, 1900s with original cabinet and accessories. $70. 0401 782 722 f031025
SMALL bar fridge in good working order $100. 6649 1472 F160525
SMALL mobile bench 2 shelves, suit shop or office. $40. 6652 3791
SNOW skis 2019 Volkyl Flair SC 150cm Black Marker bindings, + free Atomic ski boots (women’s 24.5cm) and poles. $75. 0435 131 589 F290825
SOUND Bar 2.0.2 CH 120W Dolby ATMOS 12 months old with 2 built in subwoofers. Price $100 Ph 0412 081 950
STAMPS date back to 1900 and prior. First Day Covers unopened 19612004. Offers. Ph Wyn 0417 969 322
STOOL seats. Variety size, type and colour. $30 6652 3791
SUITCASES - X Large $15, Large $10, Med $5 0481 966 840
TEASPOONS large collection as new feat various characters $3-5 per spoon 0403 425 913
TIMBER bookcase app 5ft by 3ft. $100 0466 040 154
TOILET bowl, white Never used, still packaged with seat. Best offer. 0411 527 727F220825
single bed frames round heads & foot rail black. $50 both 0412 254 563 F310125 TWO macrame wall hangers hand made $50 both 0412 254 563 F310125
TWO small wooden childrens wheelbarrows to play or learn planting etc $70. 6652 3791
80cm (32”) + DVD

WATERBED, brand new Queen bladder inc GC. $100. 0421 086 590
WATERBED Heater 300w carbon IQ digital, exc cond $100. 0421 086 590

WETSUIT, Mad Dog. Mens, full length. 3mm neoprene. Small. Feats textured knee pads, black/blue. $90 ono 0409 716 774 Caravans
YAMAHA EF2000is Generator, new condition $1,200 Ph 0402 390 057
3.4m Savage with trailer rego, 6HP and electric swivel seats, cover safety gear, lots of extras ACF724N. L26949 $2,000. 0427 528 084 Re300525


Detailed 373K, excel cond. New battery, 3 new tires, reg Apr 2026. LTP000. Serviced by Merc mechanics. Txt Michael 0422 044 420


Pop Top

hello to Blue – a
affectionate boy with a heart as big as his smile. At around 8 years old, Blue is a golden oldie who still has plenty of love and life left to share. He’s loyal, gentle, and ready to find a family who’ll give him the second chance he deserves.
Blue is the kind of dog who just wants to




















OVER 25 YEARS EXPERIENCE Home Improvements

Contractors Licence 77993C
SPECIAIZING IN ROOF LEAKS, ROOF REPAIRS, ROOF RESTORATION, RE-ROOFING, GUTTER REPLACEMENT,
SPECIALISING IN ROOF LEAKS, ROOF REPAIRS, ROOF RESTORATION, RE-ROOFING, GUTTER REPLACEMENT, FASCIA BOARD REPLACEMENT, COLORBOND FASCIA COVER, COLORBOND EXTERIOR WALL, EAVE CLADDING AND EXTERIOR PAINTING
CLADDING
DESIGNER OF VERSATILE CLADDING MADE FROM COLORBOND SUPPLY ONLY OR SUPPLY AND INSTALL.
4 METHODS OF USE: FLUSH VERTICAL, FLUSH HORIZONTAL, OVERLAP HORIZONTAL AND EAVE LOOK


Mobile 0434 330 555 nestlershomeimprovements.com.au nestlersversatilecladding.com.au
Mobile 0434 330 555 nestlershomeimprovements.com.au nestlersversatilecladding.com.au






SATURDAY
ABC TV, 7.30pm
Having left the sun-soaked shenanigans of Saint Marie behind, this Death in Paradise spin-off delves deeper into the lives of DI Humphrey Goodman and his fiancée Martha (Kris Marshall and Sally Bretton, both pictured) as they settle into her coastal Devonshire hometown. There’s still silly crime capers (case in point: this week, Goodman joins the local players to act out a murder mystery that turns out to involve a very real knife in the victim’s back), but the focus is on the characters’ personal narratives.
SUNDAY
THE FOLLOWING EVENTS ARE BASED ON A PACK OF LIES
ABC TV, 9.05pm
Fifteen years after her husband, Rob (Sex Education pictured), vanished without a trace – along with her life savings and her parents’ retirement fund – Alice (Rebekah Staton) walks past him on the street. Alice soon discovers she’s not the only one Rob has fleeced… in fact, the conman has been operating all over the UK. While her charming cad of an exhusband sets about wooing his latest victim, widowed author Cheryl (Marianne Jean-Baptiste), Alice uses the tricks she learnt from him expose his scam. Marrying whimsy with dark humour, this revenge drama will have you falling for both sides of the story.

MONDAY THE AMAZING RACE AUSTRALIA: CELEBRITY

Energetic host Beau Ryan (pictured) always appears larger than life, but in Monday’s episode of the Race, the former NRL player takes it to another level, literally – appearing on a digital billboard above the streets of Taipei to direct the five remaining teams to their next challenge. From embracing local cuisine at the bustling markets to testing their gaming skills at an arcade and tracking down “techno dancing gods”, the teams’ Taiwanese adventure is a smorgasbord of traditional and nextgeneration cultural experiences in the crowded city. Exhaustion is beginning to set in, but there’s one final push for the pit stop.
Silent Witness. (Malv, R)
Rage New Music. (MA15+adhlnsv)
FAMILY (22)
Good Game Spawn Point. (Final) 7.55 Teen Titans Go! 8.05 Be Cool, Scooby-Doo! 8.30 BTN Newsbreak. 8.35 MythBusters “There’s Your Problem!”. 9.00 Robot Wars. 10.00 Merlin. 10.45 Late Programs.
Amazing Railway Adventures With Nick Knowles. (PGa, R)
8.25 Lost Temples Of Cambodia. (PG, R)
Rage. (PG) 6.00 Mastermind Australia. (R) 6.30 SBS World News.
9.20 Lost Treasures Of Egypt. (PG)
10.15 SBS World News Late.
10.45 Catch Me A Killer. (Malsv)
11.45 Rogue Heroes. (Malv, R)
2.00 Qatar: A Dynasty With Global Ambitions. (PGav, R)
3.00 Curious Traveller. (R)
4.00 J Schwanke’s Life In Bloom. (R)
5.00 NHK World English News Morning. 5.30 ANC Philippines The World Tonight.
6.00 Seven News. 7.00 Better Homes And Gardens. 8.30 MOVIE: Ticket To Paradise. (2022, Ml) A divorced couple team up and travel to Bali to stop their daughter from getting married. George Clooney, Julia Roberts. 10.45 Motorway Patrol. (PGl, R) 11.15 GetOn Extra. 11.45 Healthy, Wealthy & Wise. (PG, R) Presented by Chrissie Swan. 12.45 Riviera. (MA15+adlsv, R) Georgina joins forces with an unlikely ally.
2.00 Home Shopping. (R)
4.00 Million Dollar Minute. (R)
5.00 NBC Today.
6.00 NBN News.
7.00 A Current Affair.
7.30 Find My Country House Australia.
8.30 MOVIE: Expend4bles. (2023, MA15+alsv) A team of mercenaries tries to prevent World War III. Jason Statham, Sylvester Stallone. 10.30 MOVIE: The Foreigner. (2017, MA15+alv, R)
12.40 Tipping Point. (PG)
1.30 TV Shop: Home Shopping. (R)
4.00 Skippy The Bush Kangaroo. (R)
4.30 Global Shop. (R)
5.00
Postcards. (PG, R)






6.00 Rage Charts. (PG) 7.00 Wknd Brekky. 9.00 Rage. (PG) 12.00 ABC News At Noon. 12.25 Beyond Paradise. (PG, R) 1.25 Professor T. (Mav, R) 2.10 I, Jack Wright. (Mal, R) 3.00 The Larkins. (PG, R) 3.50 Julia Zemiro’s Home Delivery. (PG, R) 4.15 The Assembly. (PG, R) 5.00 Take 5 With Zan Rowe. (PGl, R) 5.30 Landline. (R)
6.00 Australian Story: Striking A Chord – Astrid Jorgensen. (R) Looks at Astrid Jorgensen.
6.30 Back Roads: Lucindale, South Australia. (PG, R)
7.00 ABC News.
7.30 Beyond Paradise. (Return, Ma) Humphrey takes part in a play.
8.30 Return To Paradise. (Mv, R) An Australian expat police detective returns to her hometown where she helps solve murders.
9.30 Mystery Road: Origin. (Mal, R) Jay’s brother Sputty is implicated in a murder.
10.30 I, Jack Wright. (Final, Mal, R) 11.15 Rage. (MA15+adhlnsv)
FAMILY (22)
6am Bing. 6.05 Bananas In Pyjamas. 6.20 Peppa Pig. 6.25 Wiggle. 6.40 Shaun The Sheep. 6.45 Paddington. 7.00 Bluey. 6.40pm Bluey’s Big Play. 7.25 Bluey. 7.30 Hard Quiz Kids. (Return) 8.00 Kids BBQ Championship. 8.40 Chopped Junior. 9.20 Fresh Off The Boat. 10.05 Abbott Elementary. 10.25 Speechless. 10.45 Pokémon: Diamond And Pearl. 11.05 Late Programs. 5.55am Numberblocks.
6.00 Morning Programs. 10.00 Rediscover Victoria. (R) 11.00 Travel Quest. (PG, R) 12.00 WorldWatch. 2.00 The Grand Finale: 2006 FIFA Film. 3.45 Motor Racing. World Rally-Raid C’ships. Round 4. BP Ultimate RallyRaid Portugal. H’lights. 4.15 Gymnastics. FIG Artistic World Challenge Cup. H’lights. 5.35 Trains At War. (PGa, R)
6.30 SBS World News.
7.30 Orient Express: A Golden Era Of Travel. (PGav)
8.25 75 Years At Longleat.
9.20 Royal Crisis: Countdown To Abdication. (PGa, R)
10.20 Great Australian Walks. (PG, R)
11.15 Homicide: Life On The Street. (Mav, R)
12.55 Murder On The Dancefloor.
1.00 Going Places With Ernie Dingo. (PGl, R)
4.00 Life In Bloom. (PG, R)
5.15 France 24 Feature.
5.30 ANC Philippines The World Tonight.
VICELAND (31)
SBS MOVIES (32)
6am The Movie
Show. 6.35 Finding Your Feet. (2017, PG) 8.40 The Importance Of Being Earnest. (2002) 10.20 After Hours. (1985, M) 12.10pm Goodbye Lenin! (2003, M, German) 2.25 The Grass Harp. (1995, PG) 4.25 The Straight Story. (1999, PG) 6.30 The Three Musketeers. (1973, PG) 8.30 Free State Of Jones. (2016, MA15+) 11.05 Adoration. (2013, MA15+) 1.10am Late Programs.
SUNDAY,
6.00 Morning Programs. 10.00 Offsiders. 10.30 World This Week. (R) 11.00 Compass. (PG, R) 11.30 Praise. (R) 12.00 News. 12.30 Landline. 1.30 Gardening Australia. (R) 2.30 David Attenborough’s Kingdom Of Plants. (R) 3.20 Grand Designs NZ. (R) 4.10 Bill Bailey’s Wild West Australia. (PG, R) 5.00 Antiques Roadshow.
6.00 Pilgrimage: The Road Through The Alps. (PG)
7.00 ABC News.
7.30 The Assembly. (PG)
8.15 Mystery Road: Origin. (Mal)
9.05 The Following Events Are Based On A Pack Of Lies. (Premiere, M)
10.05 Mother And Son. (PGdl, R)
10.35 MOVIE: Love And Other Catastrophes. (1996, Md, R)
11.55 Anh’s Brush With Fame. (PG, R)
12.25 Rage. (MA15+dhlnsv)
3.00 Ask The Doctor. (PG, R)
3.30 The Art Of... (PG, R)
4.00 Gardening Australia. (R)
5.00 Insiders. (R)
FAMILY (22)
6am Bing. 6.05
Bananas In Pyjamas. 6.20 Peppa Pig. 6.25 Wiggle. 6.40 Shaun The Sheep. 6.45 Paddington. 7.00 Bluey. 7.15 Bluey’s Big Play. 8.05 Bluey. 7.30pm Shaun The Sheep. 7.35 MOVIE: My Freaky Family. (2024, PG) 9.05 MOVIE: Hotel Transylvania: Transformania. (2022, PG) 10.25 Horrible Histories. 10.55 Abbott Elementary. 11.15 Late Programs.
6.00 Morning Programs. 9.50 Soccer. FIFA Under 20 World Cup. Group Stage. Match 32. Australia v Cuba. 12.00 WorldWatch. 12.30 PBS Washington Week. 12.55 The Point. (R) 1.00 Motor Racing. Austn Superbike C’ship. Round 7. 4.00 Sailing. SailGP. Round 10. H’lights. 5.00 Grand Tours Of Scotland’s Rivers. (R) 5.35 Trains At War. (PGa, R)
6.30 SBS World News.
7.30 Nefertiti: To Whom Belongs This Beauty? (R)
8.30 Destination Ancient Rome. (PGa, R) An exploration of ancient Rome.
10.15 Kiss The Future. (Malv, R) The story of the Siege of Sarajevo. 12.05 Humanity In Danger. (Premiere)
2.00 Auschwitz: The Hidden Traces. (Mavw, R)
3.00 Curious Traveller. (R)
4.00 J Schwanke’s Life In Bloom. (R)
5.00 NHK World English News Morning.
5.15 France 24 Feature. 5.30 APAC Weekly.
VICELAND (31)
4.45
10.00
1.00
6.00 NBC Today. 7.00 Weekend Sunrise. 10.00 The Morning Show: Wknd. (PG) 12.00 Horse Racing. Epsom Day and Turnbull Stakes Day. 5.00 Seven News At 5. 5.30 Border Security: Australia’s Front Line. (PG, R)
6.00 Seven News. 7.00 Healthy, Wealthy & Wise. (PGl) A deserving mum gets a makeover.
8.00 MOVIE: Die Hard 2. (1990, Mlv, R) A cop becomes involved in a hostage situation at an airport while waiting for his wife’s plane to arrive. Bruce Willis, Bonnie Bedelia, William Atherton.
10.30 MOVIE: The Jackal. (1997, MA15+lv, R) A jailed Irish sniper is hired by the FBI. Bruce Willis, Richard Gere.
1.00 Riviera. (MA15+adlsv, R)
3.00 Home Shopping. (R)
4.00 It’s Academic. (R)
5.00 House Of Wellness. (PG, R)
7TWO (62)
6.00 Getaway. (PG, R) 6.30 A Current Affair. (R) 7.00 Weekend Today. 10.00 Today Extra: Saturday. (PG) 12.00 Explore. (R) 12.15 The Block. (PGl,
6.00 NBN News.
7.00 A Current Affair.
7.30 Rugby Union. The Rugby Championship. Australia v New Zealand.
9.40 Test Rugby: Australia v New Zealand Post-Match.
10.30 MOVIE: Sharko: The Mark Graham Story. (2024, Mav)
12.00 Next Stop. (R)
12.30 The Garden Gurus. (R)
1.00 The Incredible Journey Presents. (PGa)
1.30 TV Shop: Home Shopping. (R)
4.30 Global Shop. (R)
5.00 TV Shop: Home Shopping. (R)
5.30 Helping Hands. (PG, R)
6.30 Bondi Rescue. (PGal, R) After a drunk reveller falls 20 metres off a cliff, lifeguards cannot believe the state he is in. 7.00 Soccer. Australia Cup. Final. Heidelberg United FC v Newcastle Jets. 10.30 Gogglebox Australia. (R) TV fanatics open up their living rooms to reveal their reactions to popular and topical TV shows.
11.30 The Gilded Age. (Man, R) Bertha, Marian, Aurora and Peggy take an overnight trip to see Clara Barton speak.
12.30 FBI: Most Wanted. (MA15+v, R) Barnes and Remy butt heads.
3.30 Home Shopping. (R) 5.00 Hour Of Power.
(64)
5.45 History’s Greatest Heists With Pierce Brosnan. 6.40 Abandoned Engineering. 8.30 Sue Perkins’ Big American Road Trip. 9.25 Uncanny. 10.35 Hudson & Rex. 11.25 Forbidden History. 12.20am Late Programs. 6am Shopping. 8.30
SBS MOVIES (32)
6am The Straight Story. (1999, PG) 8.05 The Movie Show. 8.40 The Three Musketeers. (1973, PG) 10.35 The Assistant. (2019, M) 12.15pm The Promise. (2016, M) 2.40 Sidonie In Japan. (2023, PG, French) 4.30 Finding Your Feet. (2017, PG) 6.35 Casablanca. (1942, PG) 8.30 Michael Clayton. (2007, MA15+) 10.40 Sing Street. (2016, M) 12.40am Free State Of Jones. (2016, MA15+) 3.05 Late Programs.
6.00 NBC Today. 7.00 Weekend Sunrise. 10.00 The Morning Show: Weekend. (PG) 12.00 Bathurst Preview Show. 1.00 House Of Wellness. (PG, R) 2.00 Behind Behani. (PGa, R) 2.30 To Be Advised. 4.10 Motorbike Cops. (PG, R) 4.30 Border Security: Int. (PG, R) 5.00 Seven News At 5. 5.30 Sydney Weekender.
6.00 Seven News. 7.00 The 1% Club. (PGl, R)
8.00 Andrew And Fergie: Duke And Duchess Of Excess. (Premiere) Examines the duke and duchess’s journey.
9.30 MOVIE: The Bee Gees: How Can You Mend A Broken Heart. (2020, Ml, R) An exploration of the Bee Gees. Barry Gibb.
12.00 Miniseries: The Victim. (Mav, R)
1.15 Travel Oz. (PG, R)
2.00 Home Shopping. (R)
3.30 Million Dollar Minute. (R)
4.00 NBC Today.
5.00 Sunrise Early News.
5.30 Sunrise.
7TWO (62)
(82)
6.
(64)
v Liverpool.
2.15 Australian Roulette. 3.05 Ski Rescue Down Under. 4.05 Hot Wheels. 5.05 MOVIE: Wonder. (2017, PG) 7.30 MOVIE: She’s The Man. (2006, PG) 9.35 MOVIE: Stick It.
With 6am Morning Programs. 11.30 The 4WD Adventure Show. Noon Blokesworld. 12.30 Timbersports. 1.00 Football. AFL Women’s. Round 8. GWS Giants v St Kilda. 3.00 Football. AFL Women’s. Round 8. North Melbourne v Sydney. 5.00 Counting Cars. 6.00 Pawn Stars. 7.00 Storage Wars. 7.30 MOVIE: Spider-Man 2. (2004,
6.00 NBN News. 6.30 Grand Final Night. 7.30 Rugby League. NRL. Grand Final. Melbourne Storm v Brisbane Broncos. 9.30 NRL Grand Final Post-Match. From Accor Stadium, Sydney. 10.45 Mobsters: Paul Castellano. (Madv) 11.45 Australia’s Top Ten Of Everything. (Mls, R) 12.40 The Gulf. (Madlsv, R) 1.30 TV Shop: Home Shopping. (R) 4.00 Believer’s Voice Of Victory. (PGa) 4.30 The Garden Gurus. (R) 5.00 Today Early News. 5.30 Today.
(82)
6.00 10 News+. Hosted by Denham Hitchcock and Amelia Brace.
7.00 The Amazing Race Australia: Celebrity Edition. (PGl) Hosted by Beau Ryan.
8.30 The Graham Norton Show. Graham Norton is joined by Taylor Swift, Cillian Murphy, Greta Lee, Jodie TurnerSmith, Domhnall Gleeson and Lewis Capaldi. 9.40 FBI. (Mv, R) The team fears a city-wide gang war is imminent after a series of bombings targets Queens. 11.30 10 News+. (R) Hosted by Denham Hitchcock and Amelia Brace. 12.30 Home Shopping. (R) 4.30 CBS Mornings.
3.00
Programs.
Of
3.30 Made In Korea: The K-Pop Experience. 4.30




TV (2)
6.00 News. 9.00 ABC News Mornings. 10.00 Teenage Boss: Next Level. (R) 10.30 Endeavour. (Mav, R) 12.00 ABC News At Noon. 1.00 Landline. (R) 2.00 Restoration Australia. (R) 2.55 Anh’s Brush With Fame. (PG, R) 3.25 Grand Designs. (R) 4.10 Long Lost Family. (PG, R) 5.00 Antiques Roadshow. (R)
6.00 Morning Programs. 10.15 Confucius Was A Foodie. (PGaw, R) 11.10 Eye In The Sky: Australia. 12.10 WorldWatch. 2.00 Ancient Egypt: Chronicles Of An Empire. (Mav, R) 3.00 Unlocking The Secrets Of Stonehenge. (PGah, R) 3.45 The Cook Up. (R) 4.15 Who Do You Think You Are? (PGa, R) 5.05 Jeopardy! 5.30 Letters And Numbers. (R)
6.00 Mastermind Australia. (R)
6.30 SBS World News.
7.30 Robson Green’s Weekend Escapes. (PG)
8.40 Railway Revolution: How Trains
Shaped Our World. (Premiere)
10.20 SBS World News Late.
10.50 Mayflies. (Mal, R)
11.55 The Allegation. (Mav, R)
2.30 Curious Traveller. (R)
3.35 J Schwanke’s Life In Bloom. (R)
4.35 Bamay. (R)
5.00 NHK World English News Morning.
5.30 ANC Philippines The World Tonight.
6am Children’s Programs. 6pm Octonauts: Above And Beyond. 6.10 PJ Masks Power Heroes. 6.20 Bluey. 6.30 Paddington. 6.40 Hey Duggee. 6.50 Ben And Holly. 7.00 Supertato. 7.05 Piripenguins. 7.20 Bluey. 7.30 Shaun The Sheep. 7.35 Ninjago: Dragons Rising. 8.00 Operation Ouch! 8.30 BTN Newsbreak. 8.35 Gladiators. 9.35 The Crystal Maze. 10.20 Merlin. 11.05 Late Programs.
6.00 NBN News.
6.00 Seven News.
7.00 Home And Away. (PG)
7.30 My Kitchen Rules. (PGl) Hosted by Colin Fassnidge and Manu Feildel. 9.00 The Rookie. (Madv) The team mobilises to locate a suspect.
10.00 Alert: Missing Persons Unit. (Mav)
11.00 S.W.A.T. (Mav)
12.00 The Great Diamond Heist. (PGa, R)
1.00 Travel Oz. (PG, R)
2.00 Home Shopping. (R)
4.00 NBC Today. 5.00 Sunrise Early News.
5.30 Sunrise.
VICELAND (31)
6.00 10 News+. 7.00
7.00 A Current Affair.
7.30 The Block. (PGl)
9.10 Murder Down Under: The Toolbox Murders Pt 1. (MA15+adv)
10.10 9News Late.
10.40 The Equalizer. (Return, MA15+v) 11.35 Transplant. (MA15+m, R)
12.30 Tipping Point. (PG, R)
1.30 TV Shop: Home Shopping. (R)
2.30 Global Shop. (R)
3.00 TV Shop: Home Shopping. (R)
4.00 Believer’s Voice Of Victory. (PGa)
4.30 A Current Affair. (R) 5.00 Today Early News. 5.30 Today.
(82)
6am Casablanca.
Continued. (1942, PG) 7.35 The Movie Show. 8.10
Sidonie In Japan. (2023, PG, French) 10.00 The Last Emperor. (1987, M) 1pm The Straight Story. (1999, PG) 3.05 The Three Musketeers. (1973, PG) 5.05 The Legend Of The Christmas Witch. (2018, PG, Italian) 6.55 Where The Money Is. (2000, PG) 8.30 Bad Company. (1972) 10.15 November. (2022, M, French) 12.15am Late Programs.
6.00 News. 9.00 News. 10.00 Aust Story. (R) 10.30 Planet America. (R) 11.00 Antiques Roadshow. (R) 12.00 ABC News At Noon. 1.00 The Following Events Are Based On A Pack Of Lies. (M, R) 2.00 Parliament Question Time. 2.55 Anh’s Brush With Fame. (PG, R) 3.25 Grand Designs. (R) 4.15 Long Lost Family. (PG, R) 5.00 Antiques Roadshow. (R)
& I. (2020, PG, R)
1.15 Grand Designs. (R) 2.05 Long Lost Family. (PG, R) 2.50 Rage. (MA15+adhlnsv) 3.30 Parkinson In Australia. (PG, R) 4.30 Gardening Australia. (R) 5.30 7.30. (R)
6am Children’s Programs.
6.00 Morning Programs. 10.05 Confucius Was A Foodie. (PGa, R) 11.00 Eye In The Sky: Australia. 12.00 WorldWatch. 2.00 Ancient Egypt: Chronicles Of An Empire. (PGa, R) 3.00 The Hunt For Cleopatra’s Missing Tomb. (PGa, R) 3.45 The Cook Up. (R) 4.15 Who Do You Think You
6.00 Mastermind Australia. (PG, R)
6.30 SBS World News.
7.30 Great British Railway Journeys. (PGv) 8.30 Insight.
9.30 Dateline.
10.00 SBS World News Late.
10.30 The Point. (R)
11.30 Spies Of Terror. (Malv)
1.25 Charles I: Downfall Of A King. (R)
2.30 Curious Traveller. (R)
3.35 J Schwanke’s Life In Bloom. (R)
4.35 Bamay. (R)
5.00 NHK World English News Morning. 5.30 ANC Philippines The World Tonight.
VICELAND (31)
2.20 Bamay. 2.50 The Mega-Brands That Built The World. 3.40 News. 3.45 WorldWatch. 5.45 The Food That Built The World. 6.35 Jeopardy! 7.30 8 Out Of 10 Cats Does Countdown. 8.30 Alone. 9.40 Hoarders. 11.20 Calipari: Razor’s Edge. 12.10am The Nine Lives Of. 1.50 Late Programs.
MOVIES (32) SBS MOVIES (32)
6am Sidonie In Japan. (2023, PG, French) 7.50 The Movie Show. 8.25 Where The Money Is. (2000, PG) 10.00 Sing Street. (2016, M) Noon 20th Century Women. (2016, M) 2.10 The Legend Of The Christmas Witch. (2018, PG, Italian) 3.55 Fried Green Tomatoes. (1991, PG) 6.15 First Cow. (2019, PG) 8.30 Unforgiven. (2013, MA15+, Japanese) 11.05 Iceman. (2017, MA15+, Rhaetic) 12.50am Late Programs.
6.00 Seven News. 7.00 Home And Away. (PG)
7.30 My Kitchen Rules. (PGl) Hosted by Colin Fassnidge and Manu Feildel.
9.10 Murder In A Small Town. (M) The team investigates when a body is found at a local wedding between members of two feuding families.
10.10 Grosse Pointe Garden Society. (Masv) Brett’s new bond stirs buzz.
11.10 The Agenda Setters.
12.10 Pretty Hard Cases. (Madv)
2.00 Home Shopping. (R)
4.00 NBC Today.
5.00 Sunrise Early News. 5.30 Sunrise.
7TWO (62) 7TWO (62)
6.00 NBN News. 7.00 A Current Affair. 7.30 The Block. (PGl) 8.40 Bump. (Premiere, Madls) 10.00 9News Late.
To Be Advised.
Forensics: Murder Scene. (MA15+av, R)
Tipping Point. (PG, R)
TV Shop: Home Shopping. (R)
Skippy The Bush Kangaroo. (R)
TV Shop: Home Shopping. (R)
Believer’s Voice Of Victory. (PGa)
A Current Affair. (R)






6am Children’s Programs. 6pm Octonauts: Above And Beyond. 6.10 PJ Masks Power Heroes. 6.20 Bluey. 6.30 Paddington. 6.40 Hey Duggee. 6.50 Ben And Holly. 7.00 Supertato. 7.05 Piripenguins. 7.20 Bluey. 7.30 Shaun The Sheep. 7.35 Ninjago: Dragons Rising. 8.00 Operation Ouch! 8.30 BTN Newsbreak. 8.35 Fresh Off The Boat. 9.15 Wallace And Gromit: A
6.00 Mastermind Australia. (R)
6.30 SBS World News.
7.30 The People Vs Robodebt. (Final, Mal)
8.40 Great British Train Journeys From Above. (Premiere, PG)
9.35 Code Of Silence. (Malv)
10.30 SBS World News Late. 11.00 COBRA. (Mal)
11.50 Freezing Embrace. (Mals, R)
1.35 Charles I: Downfall Of A King. (PGav, R)
2.40 Curious Traveller. (R) 3.45 J Schwanke’s Life In Bloom. (R) 4.40 Bamay. (R) 5.00 NHK World English News Morning. 5.30 ANC Philippines The World Tonight.
6.00 Seven News.
7.00 Home And Away. (PG)
7.30 RFDS. (Ma) Eliza second guesses herself.
8.30 Off The Grid With Colin And Manu. (M) Hosted by Colin Fassnidge and Manu Feildel.
9.30 House Of Wellness. (PG) Experts share advice on living well.
10.30 Chicago Fire. (Mas)
11.30 Lopez Vs. Lopez. (PGal)
12.00 Imposters. (Madlsv, R)
2.00 Home Shopping. (R)
4.00 NBC Today. 5.00 Sunrise Early News.
5.30 Sunrise.
6.00 NBN News.
A Current Affair.
The Block. (PGl)
Sydney 2000. Looks at the Sydney 2000 Olympics 25 years on.
The Grand Tour. (Ml)
9News Late.
THURSDAY,
Long Lost Family. (PG, R)
Rage. (MA15+adhlnsv)
Parkinson In Australia. (PG, R) 4.30 Gardening Australia. (R) 5.30 7.30. (R)
(64)
6am Morning
Programs. 6.55 The Legend Of The Christmas Witch. (2018, PG, Italian) 8.45 First Cow. (2019, PG) 11.05 Bad Company. (1972) 12.50pm November. (2022, M, French) 2.50 Murder Party. (2022, PG, French) 4.50 Where The Money Is. (2000, PG) 6.25 The Straight Story. (1999, PG) 8.30 The Drover’s Wife. (2021, MA15+) 10.30 Heathers. (1988, MA15+) 12.30am Late Programs.
6.00 Mastermind Australia. (R)
6.30 SBS World News.
7.30 Eurostar: Minding The Gap. (R)
8.30 Scandinavia With Simon Reeve. (Premiere) 9.40 Blue Lights. (Return)
10.40 SBS World News Late. 11.10 Davos 1917. (Mlv)
12.05 The Head. (MA15+a, R)
2.00 Charles I: Downfall Of A King. (PGalv, R)
3.05 Curious Traveller. (R)
4.40 Bamay. (R)
(31) VICELAND (31)
6.00 Seven News. 7.00 Home And Away. (PGav) David struggles to contain his anger.
8.30 Jim Jefferies And Friends. (MA15+s) Jim Jefferies tells the story of the time he met and nearly killed his comedy idol John Cleese.
9.30 The Amazing Race. (PG) The teams head to Prague, but their train plans are soon thrown into chaos.
11.00 Gatecrashers.
12.00 Life. (Malsv, R)
4.10 J Schwanke’s Life In Bloom. (R)
5.00 NHK World English News Morning. 5.30 ANC Philippines The World Tonight.
SBS MOVIES (32) SBS MOVIES (32)
6am Murder Party. Continued. (2022, PG, French) 6.40 The Straight Story. (1999, PG) 8.40 Fried Green Tomatoes. (1991, PG) 11.05 The Te$t. (2022, M, Spanish) 1.05pm Long Story Short. (2021, M) 2.50 First Cow. (2019, PG) 5.05 Mosley. (2019, PG) 6.55 All At Sea. (2010, PG) 8.30 The Thicket. (2024, M) 10.30 Master Gardener. (2022, M) 12.35am The Drover’s Wife. (2021, MA15+) 2.35 Late Programs.


2.00 Home Shopping. (R)
4.00 NBC Today.
5.00 Sunrise Early News.
5.30 Sunrise.
(64)





By Aiden BURGESS
ANGUS Anderson has played a big part in helping his team win a premiership in one of the countries best Australian Rules competitions.
The former Sawtell/ Toormina Saints player was awarded best on ground in Sturt’s grand final victory against Glenelg, as they won this year’s South Australian National Football League (SANFL) premiership.
The 22-year-old won the Jack Oatey Medal as the best player of the grand final, after having 24 disposals, nine marks, four clearances
CONTINUED Page 22





